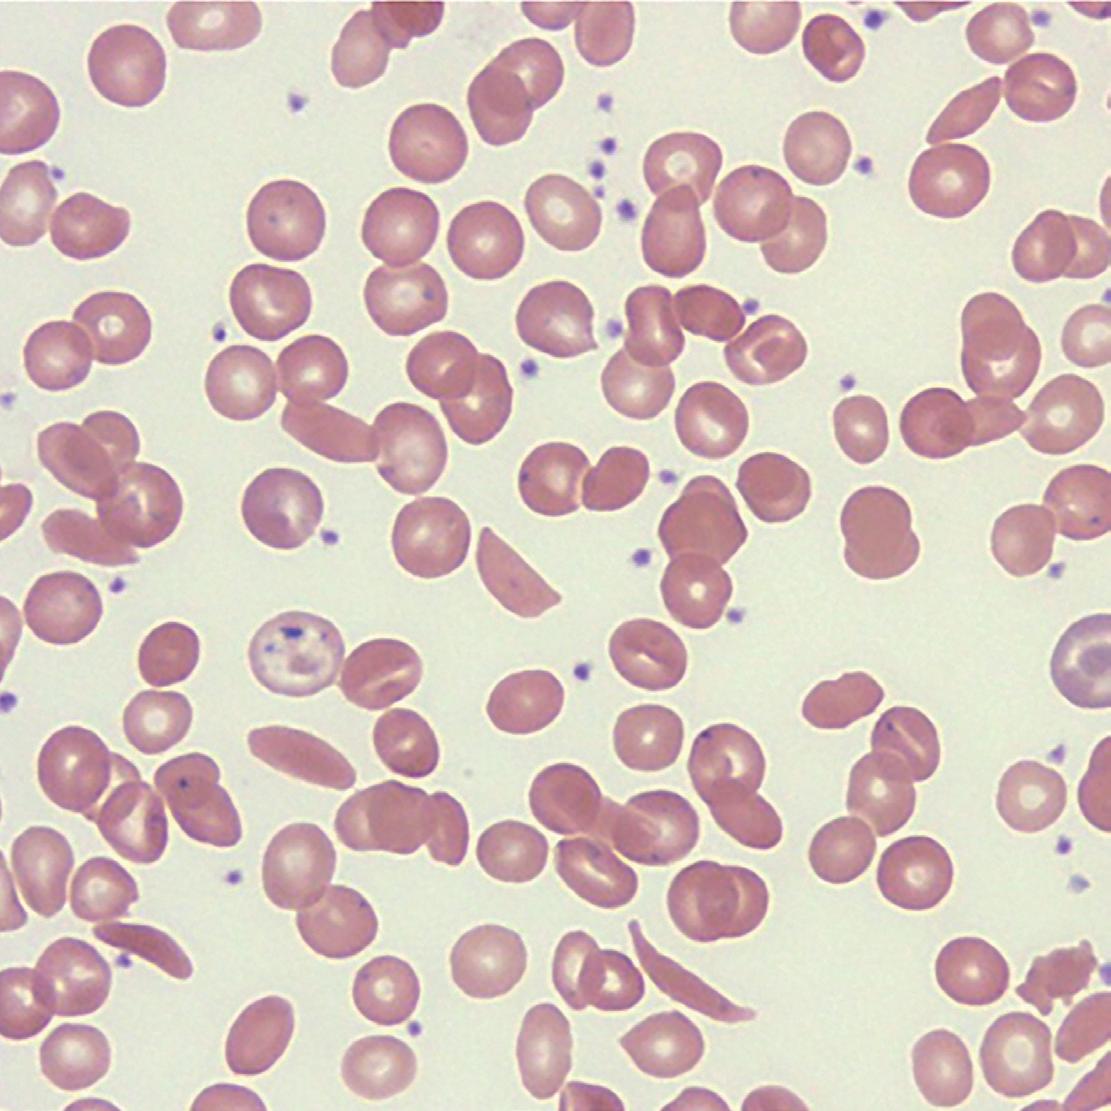

![]()


En studie publisert i 2023 hadde som mål å undersøke effektene av en mysebasert spesialnæring med humane melkeoligosakkarider 2’-FL og LNnT* (HMO) på tarmmikrobiomet og metabolomet hos ikke-ammede spedbarn med kumelkproteinallergi (KMPA) frem til 12 måneders alder. Den randomiserte kontrollerte studien inkluderte 194 spedbarn, og avføringsprøver ble samlet inn ved ulike tidspunkter. Resultatene viste at tilskudd av HMO førte til en økning i bifidobakterier i tarmmikrobiomet og forsinket endringen av mikrobiomsammensetningen mot et voksenlignende mønster.1 Den langsommere overgangen ses spesielt hos ammede spedbarn og er derfor også ønskelig hos barn der amming ikke er mulig. 2 Totalt sett korrigerte HMO-tilskuddet delvis dysbiose som ofte ses hos spedbarn med KMPA.1
2’-FL og LNnT bidro til et mer aldersriktig tarmmikrobiom og fremmet immunmodulerende effekter, inkludert en lavere forekomst av luftveisinfeksjoner og mellomørebetennelse.1,3


Kun for helsepersonell


















VIGTIG INFORMATION: Mødre skal oppmuntres til å fortsette amming selv om barnet har kumelkproteinallergi. Dette krever ofte rådgivning av kvalifisert helsepersonell, for å utelukke kumelkprotein i kosten til mødrene. Dersom det besluttes å bruke spesialnæring, som kostbehandling til spedbarnet er det viktig å gi korrekte tilberedningsinstruksjoner hvor det vektlegges at ukokt vann, usteriliserte flasker eller feilaktig blanding kan føre til sykdom. Næringsmidler til spesielle medisinske formål (FSMP) som er utviklet for å oppfylle ernæringsbehovet til spedbarn skal brukes under medisinsk tilsyn.
*2’fukosyllaktose (2’FL) og Lakto-N-neotetraose (LNnT), ikke fra morsmelk. **Når amming ikke er mulig.
REFERANCER: 1. Boulangé CL, et al. An Extensively Hydrolyzed Formula Supplemented with Two Human Milk Oligosaccharides Modifies the Fecal Microbiome and Metabolome in Infants with Cow’s Milk Protein Allergy. Int J Mol Sci. 2023 Jul 13;24(14):11422. 2. Ho NT, et al. Meta-analysis of effects of exclusive breastfeeding on infant gut microbiota across populations. Nat Commun. 2018 Oct 9;9(1):4169. 3. Vandenplas Y, et al. Effects of an Extensively Hydrolyzed Formula Supplemented with Two Human Milk Oligosaccharides on Growth, Tolerability, Safety and Infection Risk in Infants with Cow’s Milk Protein Allergy: A Randomized, Multi-Center Trial. Nutrients. 2022 Jan 26;14(3):530.
Nestlé Health Science Postboks 683, Skøyen, 0214 Oslo www.nestlehealthscience.no

Hege Kristiansen, leder NBF, leder@barnelegeforeningen.no
Mange byggestener må på plass for å gi et godt barneliv og en god barnehelse. De viktigste er kanskje gode relasjoner til familie og venner, søvn, sunn mat og drikke, mestringsopplevelser og en opplevelse av mening. Det er sikkert flere enn meg som strever med å finne ut hvordan vår tids bruk av skjerm skal passe inn i dette bildet.
På årsmøtet i Norsk barnelegeforening (NBF) i fjor fikk vi i styret et sterkt signal om å være mer synlige. Barnelegeforeningen og interessegruppene er svært synlige for våre myndigheter når vi avgir høringssvar, og dette gir reell påvirkning. Høringssvar er jo ikke så synlige for oss barneleger, men vi skal ikke undervurdere effekten. Likevel var det nok ikke gjennom flere høringer årsmøtet ønsket at NBF skulle være mer synlig. Det var nok på andre arenaer. En slik arena er Arendalsuka.



Nbf deltok i Hjernerådets debatt om skjerm.
NBF er sammen med mange andre foreninger medlem av paraplyorganisasjonen Hjernerådet. Hjernerådet stiller med Hjerneteltet under Arendalsuka, og NBF var i år en av de heldige som fikk lov å ha et arrangement der, i samarbeid med Hjernerådet. Vi valgte å ta opp temaet barn og skjerm. Dette er et tema som opptar mange av oss hver eneste dag, enten gjennom samtaler med pasienter og familier, eller i våre egne liv og familieliv. I høst kommer det også en NOU (Norges offentlige utredninger) om nettopp barn og skjerm. For å komme med best mulig innspill til dette førende dokumentet, har NBF satt ned en liten arbeidsgruppe, i samarbeid med Norsk psykologforening og Norsk barne- og ungdomspsykiatrisk forening, for å se på litteraturen. Hva vet vi egentlig? Hva vet vi om hva barn trenger for å utvikle seg godt? Står skjerm i konflikt med det?
På Arendalsuka inviterte NBF til en faglig samtale med Ann Karin Swang, leder av Faggruppe for Helsesykepleiere i Norsk sykepleierforbund, Sean Wallace, barnenevrolog på OUS og leder av Norsk barnenevrologisk forening og Mike Stilson og Sven Bisgaard Sundet fra NRK, som i høst kommer med serien Avlogga. Disse to småbarnsfedrene oppdaget at deres egen skjermbruk tok fokus vekk fra barna, og gjorde at de ikke fungerte i farsrollen slik de ønsket. Nå har de forsøkt å være avlogga skjermer i et år, og på Arendalsuka fortalte de om sine erfaringer. De er tydelige på at deres liv har endret seg til det bedre, og jobber for at samfunnet skal legge bedre til rette for å unngå skjermer og skjermavhengighet.
Samtalen ble opplysende og inspirerende. Det var godt å se at i et fullsatt Hjernetelt satt alle tilhørerne som tente lys – helt uten å se på mobilene. Arrangementet var et av de mest besøkte live, via strømming og også i opptak senere. Det er jo selvsagt ironisk å bli glad for at vi nådde ut til så mange –nettopp via skjerm. Opptaket er fortsatt tilgjengelig, du finner det på NBFs sosiale medier – hvis du ikke har slettet alt slikt. Jeg har tatt grep etter sommeren og er blitt mer bevisst på å ikke bruke skjerm i ledige øyeblikk. Det er godt – jeg hadde jo egentlig litt tid å bruke på enda kjekkere ting, viste det seg. Kanskje du blir inspirert til det samme, til glede for deg selv og de rundt deg?
Nå gjenstår det fortsatt en del viktig arbeid rundt barn og skjem for NBF – blant annet med innspill til NOU-en og senere i form av høringssvar og offentlig debatt. Vi skal fortsette med både den «usynlige» og den åpenbare synligheten, og påvirke der vi kan, til det beste for barn og unge.
Denne sommeren og tidlig høst har vært litt uvanlig værmessig, og mange av oss tenker nok mye på klimaendringer. Grønt sykehus er også et tema som opptar oss i NBF. Vi presenterte dette arbeidet på vårmøtet på Kalnes, og det er ikke tvil om at vi har barnelegene med oss i dette. Andre viktige temaer vi arbeider med for tiden er organdonasjon hos barn, samt bedre informasjon til barn på sykehus. Vi gleder oss også til å sende LIS-leger på europeisk barnelegekonferanse med stipend fra NBF. Vi oppfordrer alle interesserte LIS-er til å søke.
Jeg ønsker dere alle en riktig god høst!

Revestive er indisert til behandling av pasienter i alderen 4 måneder korrigert gestasjonsalder og eldre med kort tarm-syndrom (Short Bowel Syndrome, SBS). Pasienter bør være stabile etter en periode med intestinal adapsjon etter kirurgi.1
REVESTIVE (teduglutid)
1,25 mg og 5 mg, pulver og væske til injeksjonsvæske, oppløsning
Indikasjon: Revestive er indisert til behandling av pasienter i alderen 4 måneder korrigert gestasjonsalder og eldre med kort tarm-syndrom (Short Bowel Syndrome, SBS). Pasienter bør være stabile etter en periode med intestinal adapsjon etter kirurgi.
Kontraindikasjoner: Overfølsomhet for tetrasyklinrester. Aktivt eller mistenkt malignitet. Malignitet i mage-tarmkanalen, inkl. lever- og gallesystemet samt pankreas i løpet av de siste 5 årene Forsiktighetsregler: En koloskopi med fjerning av polypper bør gjennomføres ved oppstart av behandling. Før behandlingsoppstart hos barn bør det tas prøver for okkult blod i avføringen, deretter årlige prøver. Ved symptomer relatert til galleblæren eller galleganger, bivirkninger i pankreas, gjentagende tarmobstruksjon skal behovet for fortsatt behandling med Revestive revurderes. Bør ikke brukes under graviditet og amming. Hyppigst rapporterte bivirkninger: Abdominal smerte og distensjon, luftveisinfeksjoner (inklusiv nasofaryngitt, influensa, øvre luftveisinfeksjon og nedre luftveisinfeksjon), kvalme, reaksjoner på injeksjonsstedet, hodepine og oppkast. Pasienter med gastrointestinal stomi opplevde komplikasjoner med stomien. Dosering: Preparatnavn og produksjonsnr. skal noteres i pasientjournalen. Behandling av voksne og barn skal startes opp under veiledning av helsepersonell med erfaring i behandling av hhv. SBS og pediatrisk SBS. Optimalisering og stabilisering av i.v. væske og ernæring bør være gjennomført før behandlingsstart. Voksne inkl. eldre >65 år: Hetteglass 5 mg: 0,05 mg/kg kroppsvekt 1 gang daglig. Forsiktig nedtitrering av daglig dose kan vurderes for å optimere toleransen av behandlingen. Rekonstituert Revestive gis som s.c. injeksjon i magen, ev. i låret hvis dette ikke er mulig. Skal ikke gis i.v. eller i.m. Barn og ungdom 4 mnd korrigert gestasjonsalder - 17 år: 0,05 mg/kg kroppsvekt 1 gang daglig. Kroppsvekt >20 kg: Hetteglass 5 mg brukes.
Pakninger, priser og refusjon: 1,25 mg: 1 sett (28 hettegl. m/pulver + 28 ferdigfylte sprøyter m/oppløsningsvæske) kr. 110 579,10. H-resept. 5 mg: 1 sett (28 hettegl. m/ pulver + 28 ferdigfylte sprøyter m/oppløsningsvæske) kr. 226537,10. H-resept.
Reseptgruppe: C.
For fullstendig preparatomtale, se Revestive SPC (godkjent 19.06.2023) www.legemiddelsok.no
1. 1. Revestive SPC (godkjent 19.06.2023) avsnitt 4.1. Se www.legemiddelsok.no
2. Revestive SPC (godkjent 19.06.2023) avsnitt 4.1-4.6 og 4.8. Se www.legemiddelsok.no
Katrine Engen, paidos@barnelegeforeningen.no
Da jeg gikk på videregående jobbet jeg på bakeri. Jeg tror det var formativt for at jeg senere valgte et yrke forankret i lindring, helbredelse og trøst.
Selv om jeg ikke bekjenner meg til tro på helbredelse ved kake er det definitivt både lindring og trøst i kanelboller. I moderate mengder er det ikke særlig skade forbundet med å selge kake heller. Da regner jeg ikke med tertene med sviskekrem som fløt rundt i disken i trekvart år. Oppgaven burde være enkel. Forsyne mennesker med gluten mot valuta. Tilberede og klargjøre salgsobjektene på en slik måte at kjøper fremviste fornøyd kundeopplevelse. For alle dere uinnvidde så betyr det mersalg. Det er litt det samme som å være slepphendt med MR-rekvisisjoner.
I virkeligheten var det ikke alltid enkelt å skape gode kundeopplevelser. Selv i det provinsielle Østfold lot ikke folk seg avspise med kort og konsis kneipp over disk. Vi måtte hoste opp langt bedre enn det. Hver tidligvakt startet med nøye planlagt presentasjon av dagens bolleleveranse, dandert litt sånn festlig rustikt med noe rødrutete ræl i bakgrunnen. «Koselig, koselig, koselig» messet jeg for meg selv, mens jeg kvestet de lubne, små fjesene deres med baksiden av en stekespade, for deretter å sminke dem enda koseligere med melis og bleke importjordbær.

Redaktørens epistel forfattes i værfast tilstand som ufrivillig oppbevaringsgjest på Scandic. Ferien endte på en stengt flyplass med kansellert SK-rushtid fra Gokk. Vel fremme ved skranken etter en ombookingskø på lengde med norskekysten kjente jeg et umiddelbart slag i mellomgulvet. Det var ikke køutløst ny pers for blærekapasiteten som avstedkom det. Pent innrammet stod et skilt som oppfordret frustrerte reisende på diverse språk om å avstå fra «utskjelling», «stygg språkbruk» og «trusler» mot Widerøes ansatte.
«Det er for lenge siden krigen!» sukket kollegaen min en formiddag etter å ha tatt imot et verbalt karakterdrap på vegne av mengden gul krem i skillingsbollene
«Det er for lenge siden krigen!» sukket kollegaen min en formiddag etter å ha tatt imot et verbalt karakterdrap på vegne av mengden gul krem i skillingsbollene. Selv hadde jeg nettopp formidlet den tragiske beskjeden om utsolgt ostekake – til en påfølgende oppfordring om å dra til helvete.
Det er menneskelig å være menneske, og mennesker blir frustrerte. Vi blir sinte, lei oss og regressive, dårlige utgaver av oss selv. Selv for min sindigste turnuskollega rant frustrasjonsbegeret over i telefonen til Brukerstøtte da de femten innkomstjournalene hans var forsvunnet i eteren og han ikke kunne huske hvem som hadde hvilke funn ved rektaleksplorasjon. Jeg må også bekjenne at jeg kjente tålmodighetsstrikken spenne seg litt ved folk som på død og liv skulle drive allergenfri selvutvikling ved kaffemaskinen.
Iblant møter vi frustrasjon som skyter over det påregnelige i det å jobbe med mennesker i krise. Profesjonell kommunikasjon handler også om å møte frustrasjon, fortvilelse og iblant sinne. Likevel er verken trusler, utskjelling eller nedrig munnbruk ovenfor servicepersonell, leger eller andre akseptabelt eller særlig konstruktivt.
Det er derimot gjærbakst. Ta deg en bolle!

Et av barnelegeforeningens æresmedlemmer har gått bort. Professor Oddmund Søvik døde 31. mai 2024. Han feiret sin 90-årsdag 21. november 2023 og ble behørig hyllet av familie, venner og kolleger. Hans forskning har hatt stor betydning for forståelsen av diabetes, spesielt blant barn og ungdom, og hans arbeid har bidratt til bedre diagnose, behandlingsmetoder og oppfølging.
Søvik ble cand. med. i 1959 og dr. med. i 1967, begge ved Universitetet i Oslo. Fra 1973 var han overlege ved Barneklinikken, Haukeland Universitetssjukehus, og professor ved Universitetet i Bergen fra 1985.
Oddmund Søvik har vært involvert i både eksperimentell, epidemiologisk, genetisk og klinisk diabetesforskning. Han så tidlig behov for epidemiologiske studier av type 1 diabetes hos barn som viste at Norge hadde en meget høy forekomst av type 1 diabetes i aldergruppen 0-14 år og at den hadde vært økende siden 1960-tallet. De epidemiologiske studiene ledet frem til et permanent, landsomfattende, prospektivt register for diabetes hos barn og unge som nå er kjent som Nasjonalt medisinsk kvalitetsregister for barne og ungdomsdiabetes. De epidemiologiske studiene og registeret har ført frem til en rekke forskningsprosjekter og doktorgrader og har vært viktig for stadige forbedring av diabetesbehandling hos barn og unge. Han så tidlig betydning av samarbeid mellom norske barneavdelinger for å skape et fellesskap med interesse for forsknings- og kvalitetsprosjekter innen diabetes og tok initiativ til Norsk studiegruppe for barne- og ungdomsdiabetes som fortsatt har årlige møter for styrke felles mål og lære av hverandre hvordan behandle barn og unge med diabetes bedre.
Videre har Oddmund Søvik i betydelig grad bidratt til å forstå arvelige former for diabetes som MODY og utvikling av behandling for noen av disse formene bl.a. gjennom arbeidet med Norsk MODY-register. Det diagnostiske repertoar er utvidet, og det er blitt mulig med persontilpasset medisin.
Oddmund Søvik bidro også betydelig til bedret omsorg for personer med diabetes gjennom sitt arbeid i Diabetesforbundet. Han var leder av Medisinsk fagråd i en årrekke og deltok som lege på sommerleirer for barn og ungdom med diabetes. For dette mottok han Diabetesforbundets gullnål med diamant.
Han var vitenskapelig aktiv langt inn i pensjonisttilværelsen med et flertall publiserte artikler. Han har hatt en lang og rik pensjonisttilværelse som ved siden av det vitenskapelige arbeidet har omfattet bl.a. deltagelse i veteranklassen i VM i orientering. Oddmund var svært engasjert i samfunnsspørsmål og har gitt ut bøker om politikk, filosofi, religion og medisinsk etikk. Ikke minst hadde han klare synspunkter på såkalt alternativ medisin. Ikke er alle er klar over at Oddmund Søvik også gav ut flere diktsamlinger.
Oddmund Søvik framsto alltid beskjeden og uselvisk og satte ikke seg selv i sentrum. Han var en fremragende barnelege og forsker og et stort menneske. Vi lyser fred over hans minne.
Geir Joner Pål R. Njølstad

Paidos 2024
Fagpressens redaktørplakat ligger til grunn for utgivelsen. Signerte artikler og innlegg står for forfatterens egen regning, og samsvarer ikke nødvendigvis med redaksjonens eller Norsk barnelegeforenings synspunkter. Paidos forbeholder seg retten til å oppbevare og publisere artikler og annet materiale også på internett.
Paidos skal
• Sette fokus på viktige barnemedisinske tema
• Være et vindu for samfunn og media mot norsk barnemedisin
• Jobbe for økt interesse for barnehelse i et nasjonalt og internasjonalt perspektiv
• Være et medlemsblad for Norsk Barnelegeforening
ISSN: 1503-5360 Norsk barnelegeforening
Redaktør
Katrine Engen (Lillehammer) (paidos@barnelegeforeningen.no)
Redaksjonsmedarbeidere
Erle Kristensen (OUS, vararedaktør)
Kari Holte (Kalnes)
Kristoffer Brodwall (Haukeland)
Ingelin Mamen (UNN Tromsø)
Kontaktpersoner
Ingrid Wæraas Rønning (Hammerfest)
Eirin Esaiassen (UNN)
Eva Brekke (Bodø)
Alexander Aalberg (Levanger)
Beate Horsberg Eriksen (Ålesund)
Anders Bjørkhaug (Førde)
Therese Visted (Haukeland)
Ida Hausken Haugann (Haugesund)
Jon Grøtta (Elverum)
Ina Hartløff Helland (Ahus)
Kristoffer Hochnovski (Drammen)
Randi Borghild Stornes (Skien)
Jon Skranes (Arendal)
Anne Kathrine Olsen (Kristiansand)
Henrik Underthun Irgens (Nettverket)
Layout, annonser og produksjon
Apriil Media AS media@apriil.no www.apriil.no Tlf. 988 19 348
Materiellfrister/utgivelse:
Frister oppdateres på pedweb.no
Opplag: 1600
Antall utgivelser per år: 3
Paidos på nett: www.paidos.no
Abonnement
210 kr pr år/3 nr. Kan bestilles ved mail til: paidos@barnelegeforeningen.no
Lederen har ordet
Ta deg en bolle!
Minneord Oddmund Søvik
Geir Joner og Pål R. Njølstad
Oppslagstavle
Born i bilete: Akrobatfamilien
Dagfinn Skrede
Sigdcelleanemi – et nytt tilskudd til nyfødtscreeningen!
Tina Treu Os og Anne Grethe Bechensteen
Bokanmeldelse: The Song of the Cell
Kari Holte
Et strålende forbilde – Ellen Gledtisch
Katrine Engen
Cellegift hjemme til ungdom og unge voksne med sarkom
Hilde Bøgseth
Vindu mot verden: Bildebrev fra Gaza
Harald Hurum 76
Norge Rundt: Montebellosenteret: livsmestringskurs for familier med kreftsykt barn
Maria Munsters og Marianne Straume 80
Vårmøtet i Fredrikstad 2024! En bidereportasje
Highlights from Acta paediatrica

Konkurranse!
Klarer du å gjette hvem som har tegnet den flotte forsiden?
Se fasit – og ny gåte på side 56

Meld deg på pediaterdagene i Trondheim
Gusse Grevling og trønderbarnelegene er vertskap og lover spennende og fremsynt faglig påfyll.
Hold av datoene 22. – 24. januar.
Neste tema blir “lys” Frist for innsending av bidrag er 22. oktober.
Skriv til oss på e-post paidos@barnelegeforeningen.no


Ikke overraskende er kunstneren overlege Bem Zeller ved avdeling for barnekreft- og blodsykdommer, Rikshospitalet. Klarer du å gjette hvem «dobbeltgjengeren» er?
Send svaret til paidos@barnelegeforeningen.no
«Hint!» - Du vil helst ikke palpere ham...
Paidos søker nye redaksjonsmedlemmer!
Har du en kollega som skriver lange epikriser? Eller har du lyst til å bli med i legenorges mest lekne redaksjon?
Send et tips til paridos@barnelegeforeningen.no
Etter en lang prosess har Nbf i samarbeid med designfirmaet Melkeveien fått ny logo.



Utvalgte indikasjoner1
Revmatoid artritt: Voksne med revmatoid artritt (RA) i kombinasjon med metotreksat hos de som ikke oppnår tilstrekkelig effekt med metotreksat alene.
Autoinflammatoriske periodiske febersyndromer hos voksne, ungdom, barn og spedbarn (≥8 måneder med kroppsvekt ≥10 kg): Cryopyrinassosierte periodiske syndromer (CAPS) inkl. NOMID/CINCA , MWS og FCAS. Familiær middelhavsfeber (FMF), hvis hensiktsmessig i kombinasjon med kolkisin.
Stills sykdom: systemisk juvenil idiopatisk artritt (sJIA) og Stills sykdom i voksen alder (AOSD), med aktive systemiske trekk av moderat til høy sykdomsaktivitet, eller ved fortsatt sykdomsaktivitet etter behandling med NSAID eller glukokortikoider.
Kan gis som monoterapi eller i kombinasjon med andre antiinflammatoriske legemidler og DMARD.
RA: Voksne inkl. eldre: Anbefalt dose er 100 mg 1 gang daglig
CAPS: Voksne inkl. eldre, ungdom og barn ≥8 måneder og ≥10 kg:
Anbefalt startdose 1-2 mg/kg dag. FMF og Stills sykdom: Anbefalt dose 100 mg/dag ved kroppsvekt ≥50 kg. Ved kroppsvekt <50 kg justeres dosen etter kroppsvekt, med startdose 1-2 mg/kg/dag. Hos barn med utilstrekkelig respons kan dosen økes opptil 4 mg/kg/dag. Kineret skal gis subkutant i daglige injeksjoner.
Utvalgte advarsler og forsiktighetsregler1
Skal ikke initieres ved nøytropeni. Skal ikke initieres ved aktive infeksjoner.
Samtidig behandling med TNF-α-antagonister anbefales ikke pga. økt risiko for alvorlige infeksjoner.
Legemiddelreaksjon med eosinofili og systemiske symptomer . (DRESS) er rapportert i sjeldne tilfeller, hovedsakelig hos SJIA pasienter.
Utvalgte bivirkninger1
Svært vanlige:
Reaksjon på injeksjonsstedet
Hodepine
Vanlige: Nøytropeni
Trombocytopeni
Alvorlige infeksjoner
For fullstendig oversikt over bivirkninger og forsiktighetsregler: se godkjent SPC på www.felleskatalogen.no
Varenummer: 418642 Styrke: 100mg/0,67 ml
Pakning: 7 x 0,67 ml (ferdigfylt sptøyte)
Pris (AUP): 2685,20 Refusjon: H-resept, R.gr.: C
Rabattert pris- Kineret er med på LIS-anbud 2406b TNFBIO
Swedish Orphan Biovitrum AS Dronning Eufemias gate 16, 0191 Oslo Tlf.: 66 82 34 00 mail.no@sobi.com www.sobi.com/norway
For mer informasjon om Kineret: scan QR-koden / www.kineret.no


Når ein høyrer namnet Pablo Picasso (1881-1973), tenkjer nok mange på kubismen og på modernistiske verk der verda slik vi kjenner henne vert stykka opp i framande geometriske former. I motsetnad til slike seinare måleri er dette verket, Akrobatfamilien (Famille de saltimbanques) straks meir attkjenneleg - men, ved nærare gransking, ikkje mindre framandgjerande og modernistisk.
Tekst: Dagfinn Skrede, Lege i spesialisering, Barnekardiologisk avdeling, Rikshospitalet
Ikkje om du spør Picasso.
Biletet er måla i 1905, ei tid då lukka tok til å snu for unge Pablo. Etter mange år med fattigdom og vanskelege livsvilkår tok han no til å bli ein ettertrakta kunstnar. I kjærleikslivet gjekk også ting godt. På denne tida byrja Picasso å bruke varmare fargar, og åra mellom 1904-1906 kallast «den rosa perioden».
Ein treng ikkje leite lenge for å finne varme fargar i dette biletet. Sjå til dømes på skjørtet til kvinnefiguren nede til høgre, der det raudoransje signaliserer noko vitalt og kroppsleg. Dei italienske renessansemålarane, m.a. Rafael, målte ofte Jomfru Maria med raudleg skjorte som symbol på den fysiske dimensjonen hennar, medan kleda på underkroppen målte dei i blått, fargen for det himmelske og det ubesudla. At Picasso har snudd om på dette fargeskjemaet, er neppe tilfeldig. Ein kan følgje det raudoransje i ei slags linje via sjalet den vesle guten har kring skuldrane og opp til den meir intenst raude habitten som den velfødde gjøglaren har kledd seg i. Det rosa i kjolen til den vesle jenta legg også til rette for ei lun stemning i biletet.
For å balansere desse varme fargane, brukar målaren blått. Himmelen er prega av ein lystig blåturkis som vert spegla i jakka til den vesle guten. Det er òg ein litt djupare, nærmast ultramarin blå på buksa hans og på jakka til kvinna. Dette er livlege blåtonar som, heller enn å dempe dei varme fargane, skapar ein leiken harmoni i biletet.
Varme, harmoni og samspel er altså biletet rikt på - men berre om vi ser på fargane. For sjølve motivet syner oss noko heilt anna. Tre vaksne og tre born - ein familie, om vi skal tru tittelen - er avbilda i eit goldt og monokromt landskap, mykje likt Picassos heimtrakter i Andalucìa. Familiemedlemmane er nære kvarandre, men berre i romleg forstand: Blikket og kroppsspråket til kvar enkelt gjev inntrykk av at dei andre slett ikkje finst. Ingen av personane på biletet er spesielt
interessert eller engasjert i dei andre, og det er ikkje noka nemneverdig form for kommunikasjon eller emosjonell kontakt mellom dei. Dei er åleine saman. Ved fyrste augekast ser den vesle jenta ut som eit unntak, der ho kviler handa si mjukt i handa til harlekinen - men så ser vi at begge to er likesæle til det som skjer rundt dei, og at dei held hender meir av gamal vane og skikk enn av nærleik til kvarandre.
I Akrobatfamilien viser Picasso einsemda som eksistensielt grunnvilkår og minner oss om at uansett kor mange vener, familiemedlemmar, kollegaer og pasientar ein omgjev seg med, uansett kor mykje kjærleiken, gudstrua eller rusen prøver å overtyde oss om det motsette, så er mennesket til sjuande og sist åleine i verda. Livia i gangsterserien Sopranos sa det brutalt og enkelt: «in the end you die in your own arms.»
Finst det eit lyspunkt i ei slik verd, der jorda er gold og karrig og menneska låst inne i seg sjølve? Kanskje. Sjå på den vesle guten i blå jakke. Han er eit slags midtpunkt i bildekomposisjonen, både fordi bakgrunnslyset fell naturleg på andletet hans og lagar ein det som minner om ein glorie, og fordi plasseringa hans i biletet passar godt med det gylne snittet. I motsetning til dei andre, er ikkje blikket hans tomt og introspektivt, men utovervendt og retta mot noko anna, nemleg kvinneskikkelsen - mora? - nede til høgre.
Kanskje er det slik som den tyskspråklege diktaren Rainer Maria Rilke hevdar når han skriv om biletet, at eit barns ømme blikk retta mot mor kan vere ein augneblink som legitimerer ein elles tom eksistens og som må takast vare på og dyrkast som den kjæraste, skjøraste blome?
Eller er kanskje også dette blikket ein tom illusjon om fellesskap? Slik at alt som står att er einsemd og død, fargar og lys. Og kunst.
Opprinnelig var nyfødtscreeningen en test for å avdekke Følling sykdom og hypotyreose. De siste 10 årene er undersøkelsen stadig blitt utvidet til flere og flere medfødte sykdommer der et tiltak kan bedre barnets tilstand og prognose. Etter siste utvidelse testes det nå for 39 sykdommer og tilstander ved et lite hælstikk etter fødsel. Sigdcelleanemi er en av dem.
Tekst: Tina Treu Os og Anne Grethe Bechensteen, overleger ved avdeling for barnekreft- og blodsykdommer, Rikshospitalet
Nyfødtscreening er et tilbud til alle nyfødte barn i Norge, også selv om fødselen har funnet sted i utlandet. Den gjelder dermed også for asylsøkere, flyktninger, familiegjenforente, adopterte og andre som er kommet til landet.
Sigdcelleanemi er nå er en av de 39 tilstandene det screenes for. Det er derfor viktig at alle barneleger vet hva positivt funn innebærer og hvilke tiltak som skal settes i gang.
Epidemiologi
Sigdcelleanemi er en sjelden sykdom i Norge. Tilstanden er mest utbredt i Afrika, India og Midtøsten fordi bærertilstanden gir beskyttelse mot alvorlig malaria. I disse områdene forekommer sykdommen hos 1-5/10.000, og årlig blir det født omtrent 400.000 barn med sigdcelleanemi på verdensbasis. (4). Forekomsten er økende i Norge grunnet økt tilflytting fra noen regioner, men den eksakte forekomsten er ukjent. Per 2024 lever det omtrent 40 barn i Norge med tilstanden.
Etiologi og patogenese
Sigdcelleanemi er en autosomalt recessiv tilstand med livslang sykdom. Hemoglobin A (HbA) utgjør vanligvis nærmere 100% av hemoglobinet hos friske voksne og består av to α- og to β-globinkjeder. Normalt produserer ikke fosteret β-kjeder, det er erstattet av ɤ- kjeder. To α- og to ɤ kjeder danner et hemoglobinmolekyl som heter HbF (føtalt Hemoglobin). Pasienter med sigdcelleanemi har en homozygot punktmutasjon (varianten c.20A>T) i genet som koder for β-kjeden i hemoglobinet. De lager derfor ikke β-globinkjeder, og således ikke HbA, men et sigdcellehemoglobin (HbS). Barna er asymptomatiske ved fødsel fordi de har en høy
andel HbF, men får symptomer når dette faller og HbS øker i månedene etter. Sigdcellehemoglobin kan polymerisere under oksidativt stress, noe som fører til at erytrocyttene får en langstrakt sigdform.
Erytrocyttene lever vanligvis 120 dager. Celler med HbS lever mye kortere, ned til 12-15 dager. Dette fører til kronisk hemolytisk anemi. I tillegg er sigdcellene adhesive, både til hverandre og til endotel. Dette kan forårsake mikrotrombosering og vevsinfarkter som utløser det andre hovedproblemet; kriser som kan gi akutt og kronisk organskade. Sigdcellekrisene deles inn i tre typer: vasookklusive kriser, sekvestreringskriser og aplastiske kriser.
Sigdcellekriser
Hos små barn er spesielt milten utsatt. Dette kan gi akutt anemi, miltsekvestrering og redusert miltfunksjon. Vasokklusive kriser kan utløses av ulike typer stress; for eksempel kulde, infeksjoner og dehydering. Kroniske skader etter gjentatte sigdcellekriser kan ramme alle organer. Eksempler på organskade er retinopati og blindhet, hjerneslag, nyreskade og nefrotisk syndrom, hypertensjon, benmargsnekroser, leggsår og lungeskade med astma og pulmonal hypertensjon (5).
Behandling - på kort og lang sikt
Barnet behandles med hydroksyurea (hydroksykarbamid) med oppstart fra tidligst 6-9 måneders alder. Hydroksyurea er en form for cellegift som tas daglig som tablett eller mikstur. Virkningen er å øke HbF-fraksjonen som beskytter mot kriser og demper inflammasjon). Dosen økes ut fra toleranse, målt ved hematologiske verdier, og barnets vekt Ved manglende
effekt eller bivirkninger av hydroksyurea kan regelmessig utskiftningstransfusjon bli aktuelt. -
Den eneste kurative behandlingen er stamcelletransplantasjon, men på grunn av mangel på egnet donor er ikke dette aktuelt for alle. Det er anbefalt at alle barn som har en mulig søskendonor får tilbud om benmargstransplantasjon.
Det finnes flere medikamenter som foreløpig ikke er tilgjengelige eller godkjente i Norge, blant annet Voxelotor (Oxbryta) og genterapi (exagamglogene autotemcel, Casgevy). Medikamentene er tilgjengelige i EU (10).
Oppfølging
Pasientene med sigdcellesykdom trenger livslang og tverrfaglig oppfølging. Oppfølgingen består av regelmessige kontroller i henhold til «Handlingsprogrammet for sigdcelleanemi» (5). Dette innebærer kontroller hos barnehematolog/ hematolog, øyelege, kardiolog, lungelege, radiologiske undersøkelser og nevrolog. Oppfølgingen av barn er et samarbeid mellom OUS og lokalavdeling. Etter avtale vil barnet settes opp til barnehematolog ved OUS rundt 1 års alder og fra 2-16 års alder undersøkes med blant annet årlig transkraniell dopplerundersøkelse ved OUS.
I tillegg vil pasientene ha behov for tilpasset oppfølging ved organskade, for eksempel av ortoped ved benmargsnekroser eller lungelege ved astma. Barn og voksne kan ha behov for nevropsykologisk utredning og tilrettelegging på skole og arbeidsplass. Eventuelle svangerskap bør planlegges, da hydroksyurea kan være fosterskadelig.
Det er viktig med god tverrfaglig oppfølging, koordinerte helsetjenester og god informasjon til barnehage og skole. Ikke minst er det viktig med gode transisjonsforløp ved overgang fra barneavdeling til voksenavdeling. Dette gir økt forventet levealder (9).
Prognose
På grunn av kroniske og akutte organskader har pasienter med alvorlig sigdcelleanemi lavere forventet levealder, selv ved optimal medisinsk behandling. I USA er forventet levealder rundt 54-58 år (8,9). En artikkel finner at forventet levealder kan øke til 67 år ved spesialisert oppfølging ved et spesialistsenter med hematolog med god kjennskap til sykdommen, oppfølging hos ulike organspesialister, tverrfaglig oppfølging og gode transisjonsforløp fra ungdom til voksen (9). Dødeligheten for barn med sigdcelleanemi er redusert på grunn av tidligere oppstart med hydroksyurea, vaksine mot pneumokokker og profylaktisk antibiotika (9). Afrika sør for Sahara der tilgangen til medisiner og oppfølging er begrenset, har fortsatt en betydelig forhøyet barnedødelighet på 50-90% før fylte 5 år (7).
Positiv screeningprøve fra Nyfødtscreeningen – hva gjør barnelegen?
Viktig informasjon må gis
Vakthavende lege ved nyfødtscreeningen koordinerer henvisning av den nyfødte i samarbeid med barnehematolog ved OUS og vakthavende lege ved lokal barneavdeling. Disse blir enige om innkalling og informasjon av familien.
Ta følgende prøver av barnet:
• Hb, MCV, MCV, trombocytter, hvite med/diff, ferritin, kreatinin.
• Ta Hemoglobintyping av barnet. Dette gjøres delvis for å bekrefte tilstanden og delvis som utgangspunkt for senere oppfølgning
• Ta kvitteringsprøve til Nyfødtscreeningen på rødt filterkortrekvisisjon som benyttes ved ordinær nyfødtscreening. Skriv «kvitteringsprøve» i kommentarfeltet og send til Nyfødtscreeningen (for å bekrefte rett barn og screeningresultat)
Oppstart behandling
Etter bekreftet diagnose skal den nyfødte starte raskt med antibiotikaprofylakse med fenoksymetylpenicillin 125 mg to ganger daglig (2). Resepten skrives på blå resept paragraf 2, «annen immunsvikt». Barnet skal ha åpen retur til lokal barneavdeling ved feber og symptomer på sigdcellekrise og skal følges på lokal poliklinikk hver 3. måned. Barnet bør vaksineres mot pneumokokker ved 3 måneders alder, og følge barnevaksinasjonsprogrammet
Foreldrene må få opplæring i å kjenne etter forstørret milt for å kunne oppdage miltsekvestrering og informasjon om ta kontakt med sykehuset ved magesmerter og stor milt.
Hydroksyurea anbefales til alle med HbSS/HbSβ0 fra 9 måneders alder. Hos barn med alvorlige symptomer kan hydroksyurea vurderes allerede fra 6-9 måneders alder(1).
Referanser: Se paidos.no
Faktaboks 1: Screeningmetode
Filterpapirblodprøve tatt 48-72 timer etter fødsel og analysert ved qPCR test av HbS varianten c.20A>T (p.Glu7Val) i β-globinkjede genet HBB. Barn som er homozygote for HbS varianten c.20A>T er screening positive og vil bekreftes på Sangersekvensering. Barn som er heterozygote for c.20A>T vil også undersøkes med Sanger eller filtrert genomsekvensering for å identifisere andre patogene varianter (HbC, HbE, HbD-Punjab/ Los Angeles and HbO-Arab og β-globin gene varianter som Hbβ0) som sammen med c.20A>T vil ha forventet utvikling av alvorlig sigdcelleanemi. Bærere rapporteres ikke.
Faktaboks 2: Bekreftelse av diagnose Ved funn av to sykdomsgivende genvarianter i det aktuelle sykdomsgenet i DNA ekstrahert fra filterkortblodprøven, vil foreldre tilbys bærertesting som ledd i bekreftelse av barnets tilstand. Selv om genetisk testing av barnet er utført som ledd i nyfødtscreening, er det behov for prøver fra begge foreldrene for å bekrefte at genvariantene som er påvist, er lokalisert på hvert sitt allel hos barnet. Foreldretesting kan utføres på filterkort (grønt pasientfilterkortrekvisisjon) som sendes til Nyfødtscreeningen for genanalyse. Bærertest forutsetter at foreldrene har mottatt tilpasset genetisk informasjon og samtykker til test
Faktaboks 3: Register og interessegrupper Faggruppe: I 2022 ble faggruppen «Norsk Rødcellesykdommer» stiftet. Dette er en undergruppe av Norsk Hematologisk forening og består av bioingeniører, genetikere, hematologer, og barneleger. Faggruppen har 3-4 møter per år der man diskuterer kasuistikker og jobber med å lage nasjonale retningslinjer. Dersom noen ønsker å delta kan man sende e-post til leder av gruppen Marte Holmboe Berg: MarteHolmboe.Berg@lds.no
Nettverk: Våren 2023 ble det første nasjonale nettverksmøtet for benign hematologi og blødersykdommer arrangert i regi av Senter for Sjeldne diagnoser for barneleger og sykepleiere som jobber med disse sykdommene. Alle helseregioner i Norge var representert på møtet. Det er planlagt videre ett digitalt og ett fysisk møte per år.
Register: OUS har opprettet et lokal forsknings- og kvalitetsregister for genetiske anemier, og vi ønsker å få inkludert alle barn med genetisk anemi. Det er nå inkludert omtrent 120 barn i registeret. Det er i Sjeldenstrategien anbefalt at Norge tilknyttes European Reference Network (ERN) for blodsykdommer, EuroBloodNet. Vi er nå i gang med å inkludere pasienter i et underregister av ERN EuroBloodNEt for genetiske anemier og RADEEP (Rare Anemia Disorders European Epidemiological Platform). Dersom barneavdelingene har aktuelle pasienter som ikke har tilknytning til OUS er vi takknemlige for en henvisning, slik at vi kan sette opp pasientene til et videomøte.

Forfatter: Siddhartha Mukherjee
Utgivelsesår: 2022
Anmeldt av: Kari Holte, Sykehuset Østfold Kalnes
«Cellen», sa redaktør Katrine. «Tema for neste blad. Tror du det vil fungere?» - Ja, svarte jeg. – Selvfølgelig! Men… Cellen?! Kunne jeg bidra med noe til dette bladet? Jeg så meg selv sitte på en klam, grønn klappstol i Store Auditorium: Preklinikken, medisinske basalfag - en ørken av ribosomer, golgiapparat og biokjemiske reaksjoner, uten levd liv og ekte pasienter å feste kunnskapen til.
Hvis du er som jeg har du kanskje tenkt at det kunne vært interessant å ta medisinstudiet en gang til. Med noen år som doktor i bagasjen, tror jeg at jeg ville fått mange aha-opplevelser. Inspirert av Katrines tematittel gikk jeg til bokhyllen og plukket frem «The Cell», pensumbok i cellebiologi ved UiO anno 1995. Ett-tusen-to-hundre-og-nitti-fire blytunge sider. Etter to avsnitt var hjernen nummen. - Hjelp, tenkte jeg. - Dette er ugjennomtrengelig uten eksamenspanikk.
Som ofte ellers når jeg søker svar, logget jeg på pc’n. «Oppdatert kunnskap om cellebiologi uten å dø av kjedsomhet», skrev jeg i søkefeltet. Les «The Song of the Cell,» sa Google. Det har jeg gjort, i sommersola på hytta mens jeg stekte hudcellene mine, og merkelig nok døde jeg ikke en eneste gang. Tvert imot: Jeg fikk repetert mye cellebiologi og medisinsk historie samtidig som jeg lærte en god del nytt, blant annet om Covid-immunologi og CAR-T. Uten å sovne eller miste interessen mer enn kanskje, si 5 ganger, på 377 sider! For det meste følte jeg meg opplyst og inspirert mens jeg leste. Det er faktisk et lite mirakel i disse tider hvor lesekondisen knapt rekker til bunnen av en bokanmeldelse på 593 ord.
Mukherjee holdt meg fanget i lesingen ved å bryte alle regler for kald og stringent faglitterær formidling. Dette er populær-
vitenskap, men han gjør det med stil og høyt kunnskapsnivå. Boka er full av beskrivelser og skjønnlitterære kvaliteter. Språket er rikt, variert og tidvis vakkert. Ikke bare får vi være med inn på laboratoriet til Virchow, Ehrlich og en rekke litt mindre kjente navn fra cellebiologiens historie, men vi får gløtt inn i livene og hodene deres, sitater, litt bakgrunn for hvorfor de tenkte som de gjorde. Her finnes også pasienthistorier, blant annet om forfatterens venn Sam som først responderte godt på et av tidenes første forsøk med immunterapi mot malignt melanom, før behandlingen måtte stoppes på grunn av autoimmun hepatitt. Fortellingene står ikke alene, de er alltid en del av et pedagogisk poeng, illustrerende eksempler som gjør det lettere å forstå.
Hvis du tilhører de som har holdt deg oppdatert på alt og spiser Lancet til frokost, kan du trolig finne feil i boka som jeg var for dum til å oppdage. Du vil sikkert også la deg irritere over upresise overskrifter som «The visible cell» (oppfinnelsen av mikroskopet og historien om hvordan cellene ble oppdaget) og «The selfish cell» (kreft). Men jeg tror fortsatt du vil bli imponert over elegansen i språket. Og selv i savnet etter lærebokas strikse form, vil du finne trøst i et mylder av fotnoter, fyldig referanseliste og en imponerende, gjennomarbeidet indeks.
«Men er det relevant for barneleger, da?» Spør du kanskje. – Ja, vil jeg si. Forfatteren glitrer sterkest når han skriver om hematologi, immunologi og kreft, men fosterutvikling og medfødte sykdommer er også beskrevet med begeistring. For meg funket det som tusan. Boka vekket nysgjerrighet og ga meg knagger å feste teoriene på. Gøy lesing, litt læring og en god porsjon livsfilosofi. Hvis du fikk lyst til å lese, kan du låne den av meg J

Periodesystemets 88. grunnstoff har gitt navn til sykehuset som åpnet for kurativ behandling av kreftpasienter. Radium, og dermed en av grunnsteinene i moderne kreftbehandling, kom til Norge ved hjelp av landets første radiokjemiker og Marie Curies assistent. Ellen Gledtisch ble Norges andre kvinnelige professor. Fortellingen om henne er historien om fremveksten av moderne vitenskap – og kvinners rett til å være i den.
Tekst: Katrine Engen, redaktør Paidos
Epoken ble kalt «den heroiske tid». Oppdagelsen av grunnstoffet i 1898 og forklaringen på fenomenet radioaktivitet ble kronet med Nobelpris til Marie og Pierre Curie i 1903. Det etter hvert berømte laboratoriet ved Sorbonne var drømmen for vitenskapelige studieopphold. Sorbonne var Pasteur, Perrin, Rutherford og Bequerel. Datidens episenter for naturvitenskapelig forskning seigpinte Kelvins berømte uttalelse om at de fleste av fysikkens spørsmål i grunnen var ferdig klekket ut.
Ellen Gledtisch reiste til Paris i 1907 og tilbrakte fem år som elev og senere assistent under Marie Curie. Vennskapet varte livet ut. I 1916 ble hun som nyansatt universitetsdosent i radiokjemi kalt tilbake til Frankrike for å bistå Marie Curie
i hennes arbeid for å skaffe radium til transportbilene hun brukte for å hjelpe sårede i skyttergravene. De to beholdt kontakten gjennom livslang brevveksling.
Det var ingen selvfølge at hun skulle utnevnes til æresdoktor samme sted noen tiår senere. Ellen Gledtisch vokste opp i Mandal og senere Tromsø, omgitt av en familie med liberale og progressive verdier, glede over natur og friluftsliv – og en stadig voksende søskenflokk. Som eldst fikk hun ansvaret for flere av dem da foreldrene døde. Veien til høyere utdanning var lang og kronglete, til tross for toppkarakterer i både språk og realfag. Økonomiske begrensninger ble imidlertid trumfet av en solid arbeidskapasitet og et lynende intellekt. Hun tok artium ved siden av fulltidsjobb i 1902. Et amanuensisvikariat
ved kjemisk laboratorium og en liten selv stendig publikasjon senere åpnet nesten døren til Sorbonne. I utgangspunktet kunne ikke Marie Curie oppdrive plass på det allerede overfylte laboratoriet. Litt brevveksling mellom laboratoriesjefen hun vikarierte for og Curie forsikret om både briljante evner og at Gledtisch med sine 154 vevre centimeter nesten ikke tok noe plass var oppholdet sikret. Resten skulle bli banebrytende vitenskaps- og kvinnehistorie.
Gledtisch publiserte mer enn 120 artikler og gjennomførte flere selvstendige arbeider, blant annet referert til i Marie Curies berømte lærebok om radioaktiviteten. Særlig ble hun kjent for sitt arbeid om radiums halveringstid og kalibrering av stoffet. Forståelsen av dette skulle senere bli essensielt for den medisinske bruken av radium i strålebehandling.

Ellen Gledtisch var aktiv formidler innti sin død 88 år gammel. Her under Universitetets 100-årsmarkering for Marie Curies fødsel i 1967. Foto: NTB.
Til tross for akademisk forankring i kjemifaget var Ellen Gledtisch på ingen måte uten medisinsk innsikt. Hun startet som apotekerlærling i 1895 og fullførte sin praktiske farmasøytutdanning. Idealet om forskning i en humanistisk tradisjon stod sterkt i miljøet ved Sorbonne. Det var et uttalt prinsipp for både Marie og Pierre Curie at oppdagelsen av radium og mulighetene det åpnet for skulle komme medisinen og forskningen til gode. De var begge prinsipielle motstandere av økonomisk vinning på vitenskapelig arbeid.
Det hadde lenge vært et ønske fra idealistiske unge leger å få radiumbehandling til kreftpasienter ved Rikshospitalet. Blant de viktigste pådriverne var Severin Andreas Heyerdahl og Hans Ludvig Carl Huitfeldt, begge unge leger som fulgte interessert med på utviklingen av kreftbehandling med radium og røntgenstråler. Stor skepsis i etablerte fagmiljøer, manglende kunnskap om sikkerhet og håndtering og ikke minst kostnadene holdt igjen. Etter utbredt folkeengasjement, og nok også en ikke ubetydelig lobbyvirksomhet, ble budsjettrammene for å sikre innførselen av radium vedtatt i Stortinget i 1912. Ved hjelp av Ellen Gledtisch ble det første innkjøpet av radium til Norge organisert, og første pasient fullførte behandlingen samme år. Radiumhospitalet åpnet omsider med 71 senger i 1932 som landsdekkende behandlingstilbud med radiumbasert strålebehandling. Både bygg, utstyr og radium var i stor grad finansiert av innsamlingsaksjoner og gavemidler.
Adgang til artium og høyere utdanning, ledsaget av stadig viktigere milepæler i kvinners rettighetskamp ga økt aksept også for kvinner i akademiske posisjoner. Som en av de første ble hun akseptert som forsker ved Yale University i 1913. Hun
fikk sitt første æresdoktorat i 1914. Sammen med den svenske fysikeren Eva Ramstedt publiserte hun i 1917 arbeidet som skulle bli grunnlaget for hennes senere lærebok i anorganisk kjemi. Gjennom 20-tallet publiserte hun flere vitenskapelige avhandlinger innen isotopforskning og uorganisk kjemi, i tillegg til boken Radioaktivitet og Grundstofforvandling, sistnevnte til en uvanlig høy etterspørsel. Hun var sentral i stiftelsen av Norske Kvinnelige Akademikeres Landsforbund og ledet organisasjonen i flere år, samt president i den Internasjonale føderasjonen av universitetskvinner. «Det er meg knekkende likegyldig om et godt arbeid er utført av en liten dame i Bulgaria eller en lang mann i Amerika, så lenge det er godt utført» står som illustrasjon for hennes engasjement.
Professoratet fikk hun i 1929, 17 år etter at Kristine Bonnevie inntok professorstolen i biologi som første kvinne. Utnevnelsen kom etter en betent diskusjon over hvorvidt den akademiske bastionen kjemi kunne forvaltes av en kvinne. Det kunne den. Hun ble kjent for sin usedvanlige faglige kapasitet, store formidlingsevne, varme og hjelpsomhet. Det var ifølge forfatterne ikke ubegrunnet at biografien om henne fikk tittelen «Et liv i forskning og medmenneskelighet». Selv som etablert professor måtte hun møte både skepsis og motstand mot kvinner i ledende akademiske stillinger.
Etter razzia og stengning av Universitetet i 1943 hadde hun stadig hjemmefrontsoldater i dekning i leiligheten. For å kunne kommunisere rundt med folk utviklet hun en spesiell interesse for å sy bunader. Hun ble arrestert i 1944, men løslatt kort tid etter.
Det akademiske arbeidet og kontakten med Curie-instituttet i Paris gjenopptok hun raskt etter frigjøringen. Hun gikk av for aldersgrensen i 1946, men fortsatte sitt akademiske arbeid og engasjement for vitenskapen inntil sin død i 1968, 88 år gammel.
Fortsatt står Ellen Gledtisch som en av Norges høyest meritterte innen akademia og vitenskap. Like viktig står hun som en pioneer for de verdiene som først og fremst driver forskningen til det beste for menneskeheten.
Kilder:
Store Norske Leksikon Historien om Radiumhospitalet Kronen/Pappas: Ellen Gleditsch : et liv i forskning og medmenneskelighet, Oslo, Aventura, 1987
Melatonin Unimedic Pharma ATC-nr N05CH01: 1 ml mikstur, oppløsning inneholder 1 mg melatonin. Hjelpestoffer med kjent effekt 1 mg metylparahydroksybenzoat. Hjelpestoffer Glyserol (E442) Sorbinsyre, Metylparahydroksybenzoat (E218) Natriumhydroksid (til pH-justering) Vann, renset. Indikasjoner: Kortvarig behandling av jetlag hos voksne, søvnforstyrrelser (insomni) hos barn og ungdom i alderen 6–17 år med ADHD der søvnhygienetiltak er utilstrekkelige. Dosering: Voksne med jetlag: Den anbefalte dosen er 1–5 mg én time før sengetid på bestemmelsesstedet. Anbefalt startdose: 2 ml (tilsvarer 2 mg). Maksimal anbefalt døgndose: 5 ml (tilsvarer 5 mg) i maksimalt 5 dager. Pediatrisk populasjon med ADHD: Anbefalt startdose: 1–2 ml (tilsvarer 1-2 mg) 30 til 60 minutter før sengetid. Dosen skal justeres individuelt til maksimalt 5 ml (tilsvarer 5 mg) daglig uansett alder. Laveste effektive dose skal etterstrebes. Kontraindikasjoner: Overfølsomhet for innholdsstoffene. Forsiktighetsregler: Mulige langtidseffekter av melatonin har ikke vært tilstrekkelig undersøkt. Brukes med forsiktighet hos personer med epilepsi. Melatonin anbefales ikke til pasienter med autoimmune sykdommer. Dette legemidlet inneholder metylparahydroksybenzoat, som kan forårsake allergiske reaksjoner. Interaksjoner: Metaboliseres hovedsakelig via enzymet CYP1A2, bruk interaksjons-analyse for mer informasjon. Bivirkninger: Melatonin gir få og ingen alvorlige bivirkninger ved kortvarig bruk. Vanligst er fatigue, svimmelhet og hodepine. Graviditet, amming og fertilitet: På grunn av manglende data er Melatonin Unimedic Pharma ikke anbefalt under graviditet eller hos fertile kvinner uten prevensjon. Amming: Melatonin Unimedic Pharma skal ikke brukes ved amming. Fertilitet: mangler data. For farmakologiske egenskaper, se pkt. 5 i SPC. Utleveringsbestemmelse: Skal kun utleveres tilbruk på menneske. Reseptgruppe C. Pakninger og priser: Glassflaske 100 ml, kr 479. 150 ml, kr 700,40 Refusjonberettiget bruk: Barn og ungdom 6 –17 år: Behandling av insomni ved ADHD, hvor søvnhygienetiltak ikke har vært tilstrekkelig. Refusjonskoder: ICPC P81: Hyperkinetisk forstyrrelse, vilkår 163, 254 ICD F90: Hyperkinetiske forstyrrelser. Vilkår 163, 254 Vilkår: 163: Refusjon ytes kun til barn og ungdom fra og med 6 år til og med 17 år. 254: Refusjon ytes kun til pasienter med kronisk og alvorlig insomni som har: 1) nedsatt funksjon på dagtid, som økt søvnighet, humørsvingninger, svekket kognitiv eller sosial fungering, økt ulykkesrisiko, fysisk ubehag, økt bekymring rundt søvnen, og i tillegg 2) minst tre dårlige netter per uke, eller døgnrytme som ikke lar seg normalisere.
Basert på SPC godkjent av SLV 11/2023.
Indikasjoner: Kortvarig behandling av jetlag hos voksne, søvnforstyrrelser (insomni) hos barn og ungdom i alderen 6–17 år med ADHD der søvnhygienetiltak er utilstrekkelige.
Forsiktighetsregler: Mulige langtidseffekter av melatonin har ikke vært tilstrekkelig undersøkt. Brukes med forsiktighet hos personer med epilepsi. Melatonin anbefales ikke til pasienter med autoimmune sykdommer. Dette legemidlet inneholder metylparahydroksybenzoat, som kan forårsake allergiske reaksjoner.
Bivirkninger: Melatonin gir få og ingen alvorlige bivirkninger ved kortvarig bruk. Vanligst er fatigue, svimmelhet og hodepine.
Refusjonberettiget bruk: Barn og ungdom 6 –17 år: Behandling av insomni ved ADHD, hvor søvnhygienetiltak ikke har vært tilstrekkelig. Refusjonskoder: ICPC P81: Hyperkinetisk forstyrrelse, vilkår 163, 254 ICD F90: Hyperkinetiske forstyrrelser. Vilkår 163, 254 Vilkår: 163: Refusjon ytes kun til barn og ungdom fra og med 6 år til og med 17 år. 254: Refusjon ytes kun til pasienter med kronisk og alvorlig insomni som har: 1) nedsatt funksjon på dagtid, som økt søvnighet, humørsvingninger, svekket kognitiv eller sosial fungering, økt ulykkesrisiko, fysisk ubehag, økt bekymring rundt søvnen, og i tillegg 2) minst tre dårlige netter per uke, eller døgnrytme som ikke lar seg normalisere.
1 Melatonin Unimedic Pharma innvilget forhåndsgodkjent refusjon etter blåreseptforskriftens §§ 2, jf. 1b, med hjemmel i legemiddelforskriften § 14-8.
2 SPC 2023-11-15

finnes nå også i 150 ml flaske.


Melatonin Unimedic Pharma mikstur, oppløsning er registrert med indikasjonen «søvnforstyrrelser hos barn og ungdom i alderen 6 –17 år med ADHD der søvnhygienetiltak er utilstrekkelige» 2
Mikstur, oppløsning 1 mg/ml i 100 ml flaske muliggjør fleksibel dosering
➣ NYHET! Finnes nå også i 150 ml flaske
➣ Doseringssprøyte muliggjør nøyaktig og enkel dosering
➣ Nøytral smak
Artikkelen ble første gang publisert i Onkonytt nr. 2-2023
Foresatte har samtykket til republisering.
Hilde Bøgseth, kreftsykepleier med koordinerende ansvar for ungdom, avdeling for kreftbehandling, Oslo Universitetssykehus
Ingunn H. Sandven, kreftsykepleier, Quality manager, avdeling for kreftbehandling, Oslo Universitetssykehus Ivar Hompland, overlege og seksjonsleder sarkomonkologi, avdeling for kreftbehandling, Oslo Universitetssykehus
Pasientdrevet utvikling
På sengepost A8 ved Radiumhospitalet møter vi unge pasienter med alvorlig kreftsykdom. I lange behandlingsløp blir vi godt kjent og vi er privilegerte som får innblikk i pasientens og familiens ønsker. Det som går igjen er et sterkt ønske om å tilbringe minst mulig tid på sykehus, og mest mulig tid hjemme sammen med de som de er glade i.
Flere nordiske land tilbyr hjemmebehandling med cellegift for ulike pasientgrupper. Vi ønsket at behandlingen for våre ungdommer skulle forbedres, slik at de kunne tilbringe mer tid hjemme. En bærbar, brukervennlig infusjonspumpe på 10 x 10 cm som heter Cadd Solis ble løsningen. Nå får pasienter tilbud om å få cellegiften eller hydreringsvæske i forbindelse med cellegiften, i en sekk som rommer opp til 4 liter. De kan da, etter bestemte kriterier, få reise hjem, bo i leilighet i Oslo i regi av sykehuset eller bli i avdelingen, men med større bevegelsesmuligheter enn ved en vanlig infusjonspumpe og et stativ som hele tiden er i veien. Ungdommene kan være med venner, gå på skole, gå turer og delta i livet som ellers ville stått på vent
Unge og sårbare
På sengepost A8 på Radiumhospitalet behandler vi pasienter med sarkom og lymfom. Mange sarkompasienter er mellom 10 og 30 år og kommer innenfor kategorien ungdom og unge voksne. For denne pasientgruppen er det ekstra krevende å tilbringe mye tid på sykehuset og mange går glipp av både skole, jobb, fritidsaktiviteter, sosiale sammenkomster og kanskje oppfølging av sine egne barn mens de er under behandling. Det er tøft både fysisk og psykisk å skulle gjennomgå behandling som kan ta opp mot ett år. Hjemmebehandling er et viktig skritt i å hjelpe ungdom og unge voksne til å kunne ta del i hverdagen selv under behandlingstiden og være nettopp det de er, ungdommer.
Hjemmebehandling
Våren 2020, midt under covid pandemien, startet vi med hjemmebehandling til sarkompasienter, og det har fram til april 2023 blitt gitt 88 kurer fordelt på 19 pasienter i alderen 11 til 30 år. Kurene er av varighet fra 2 til 6 dager. De fleste av pasientene må innom sykehuset en gang om dagen, enten for blodprøver og cellegift, eller bare for å bytte pose i sekken. Av sikkerhetsmessige grunner er det bestemt at pasienten


ikke kan bo mer enn en time unna sykehuset. Pasientene vi har som kommer langveis fra får derfor tilbud om å bo på pasienthotellet eller i leilighet i Oslo sentrum eid av Radiumhospitalets legater.
Hjemmebehandling virker å ha spesielt stor betydning for våre palliative pasienter. Å starte langvarig cellegift på sykehus når tiden er begrenset er en stor avgjørelse for de aller fleste. Selv om håpet om bedring og remisjon er der, virker det ofte håpløst å tilbringe hver tredje uke på sykehus.
Mer ansvar for egen behandling Å få behandling hjemme krever at pasienten tar del i egen behandling. Det er laget sjekklister for hver kur som pasienten og foreldrene må læres opp i. De må selv måle det som kreves i henhold til kur og registrere dette. Blant annet må pasienter som får høydose ifosfamid (15 g/m2) kontrollere urin-stix fire ganger daglig. Sjekklisten tas med hver dag eller hver annen dag når de er her og bytter pose i sekken. De må gjennomgå pumpa med sykepleier på avdelingen, og «øve» i forbindelse med den første kuren før de kan dra hjem. Det følger med bruksveiledning i sekken, så om noe
Lukas med venner i akebakken med sekken på fanget. Sekken inneholder pumpen og væskebehandling i forbindelse med HD-metotreksat.
er glemt er det lett å finne informasjon. Pasienten selv og/ eller omsorgspersoner blir mer ansvarliggjort og håndterer dette erfaringsmessig veldig godt.
Det som er viktig å være klar over er at pasienten ikke skrives ut av sykehuset. De er innlagt på avdelingen, og pasienten og pårørende kan ringe når som helst og komme tilbake dersom de ønsker det. Og ingen skal ha hjemmebehandling om de ikke ønsker eller føler seg komfortabel med det. Det er også nyttig å bruke sekk og pumpe selv om man forblir på sykehuset. Dette gjør pasientene mer mobile, de kan gå ut når de ønsker og kan delta på aktiviteter i større grad.
Fordeler
Erfaringene til nå viser at de som får hjemmebehandling er mere aktive, de spiser bedre, sover bedre og har generelt mindre bivirkninger. De kan gjøre mer av det de vil og være mer der de vil være. Pasientene er mer fornøyde rett og slett. Vi som jobber med dette har blitt mer bevisste på at hvor viktig pasientens tid faktisk er, og prøver å gjøre det vi kan for at tiden på sykehus blir kortest mulig. Pumpen er i tillegg lettere å håndtere, da alarmene er færre sammenlignet med


hva de er på pumpene vi har på avdelingen. Alarmer kan håndteres med noen tastetrykk av pasienten selv, av og til med veiledning på telefon. Vi har foreløpig ikke opplevd noen uheldige hendelser eller komplikasjoner med hjemmebehandlingen.
Framtiden
Utviklingspotensialet for hjemmebehandling er stort, og dette er noe vi har stor tro på. Interessen for denne typen behandling er økende. Våre erfaringer er presentert både nasjonalt (Norsk sarkomgruppemøte), i Skandinavia (Skandinaviske sarkomgruppemøte) og internasjonalt (Connective Tissue Oncology Society (CTOS) møte 2022 i Vancouver, Canada). Det er startet et kvalitativt forskningsprosjekt på avdelingen for å få innblikk i pasientopplevelsen ved hjemmebehandling.
Vi mener at hjemmebehandling kan utvides til flere pasientgrupper. Dette trenger ikke være forbeholdt ungdommer og unge voksne, og vi ser for oss at mange pasienter kan ha nytte av dette i nær framtid. Det er ikke bare cellegift og hydrering som kan administreres på denne måten, også for eksempel intravenøs ernæring og antibiotika kan gis med Cadd Solis hjemme.
Lukas har sin siste kur og det er feiring på ungdomsrommet på Radiumhospitalet med ansatte og medpasienter.
Pasienthistorie - Lukas
Da han er 12 år gammel skader Lukas kneet sitt på fotballskole. I forbindelse med dette gjøres radiologiske undersøkelser. Kneskaden viste seg å være en tumor i femur. Lukas får diagnosen osteosarkom. Behandlingen han skal igjennom vil ha en varighet på cirka 9 måneder, og protokollen består av 18 cellegiftkurer og operasjon. Det innebærer svært mye tid på sykehus. Hverdagen for Lukas og familien snus på hodet, og en ny hverdag etableres. Heldigvis bor familien nærme sykehuset og han kan få mange av kurene sine som hjemmebehandling. Allerede på kur nummer tre reiser Lukas hjem med «sekken». I følge Lukas sin mamma Linda er det absolutt beste er at Lukas kan være hjemme, sove i sin egen seng og på sitt eget rom.
Lukas ble ferdig med omtrent et år med behandling våren 2023. Han er nå i fin form og uten tegn til tilbakefall. Han venter på den siste operasjonen av kneet sitt nå til høsten.
Bilder deles med tillatelse fra Lukas og foresatte.

LGS,Refusjon DS og TSC: EPIDYOLEX®finansieres avsykehus(H-resept) ogerinnførtav Beslutningsforum.2,11
EPIDYOLEX® er en tilleggsbehandling av anfall forbundet med LGS, DS og TSC.1–10
EPIDYOLEX® – betydelig og vedvarende reduksjon av anfall forbundet med LGS, DS og TSC.#1–8
EPIDYOLEX® kan forbedre pasienters ikke-anfallsrelaterte utfall, som kognisjon, atferd og kommunikasjon, slik det er rapportert av omsorgspersoner†7
EPIDYOLEX® tolereres generelt godt, med en konsistent tolerabilitetsprofil. Bivirkninger oppstår vanligvis tidlig i behandlingen og har vært forbigående og konsistente i alle LGS-, DS- og TSC-studier.‡1–6
EPIDYOLEX® er indisert til bruk som adjuvant behandling av anfall i forbindelse med LGS eller DS, gitt sammen med klobazam*, hos pasienter som er 2 år og eldre. Epidyolex® er indisert til bruk som adjuvant behandling av anfall i forbindelse med TSC hos pasienter som er 2 år og eldre.2
* Klobazam er for tiden ikke markedsført i Norge. # EPIDYOLEX® demonstrerte klinisk signifikante reduksjoner i LGS-, DS- og TSC-assosierte anfall vs. placebo i kliniske studier, samt reduksjon i alvorlighetsgrad av anfall fra baseline.2,5 † Ikke-anfallsrelaterte utfall ble evaluert ved hjelp av den globale undersøkelsen BECOME.7 ‡ De vanligste bivirkningene assosiert med EPIDYOLEX® er nedsatt appetitt, somnolens, oppkast, pyreksi, diaré og utmattelse. For mer detaljert sikkerhetsinformasjon, se preparatomtalen.2 DS, Dravet syndrom; LGS, Lennox-Gastaut syndrom; TSC, tuberøs sklerosekompleks. Referanser: 1. Thiele EA, et al. JAMA Neurol. 2021;78(3):285–292. 2. Epidyolex® Summary of Product Characteristics. Godkjent: mai 2023. 3. Patel AD, etal.Epilepsia . 2021;62(9):2228–2239. 4. Scheffer IE, et al.Epilepsia . 2021;62(10):2505–2517. 5. Privitera M, etal.Epilepsia . 2021;62:1130–1140. 6. Cohen JM, etal.Epilepsia . 2021;62:2218–2227. 7. Berg A, et al. Epilepsy Research. 2023;107280:0920–1211. 8. Thiele EA, et al. Epilepsia. 2021;62(9):2228–2239. 9. Marchese F, et al. SN Compr Clin Med. 2021;3:2167–2179. 10. Raga S, et al. Epileptic Disord. 2021;23(1):40–52 11. https://nyemetoder.no/metoder/cannabidiol-epidyolex (Dato for tilgang: 02/2024)
Dato for utarbeidelse: juli 2024. NO-EPX-2400013. Epidyolex «Cannabidiol» mikstur
Reseptgruppe: A Indikasjoner: Brukes som tilleggsbehandling, sammen med klobazam, mot anfall forbundet med Lennox-Gastaut syndrom (LGS) eller Dravet syndrom (DS) hos pasienter ≥ 2 år. Tilleggsbehandling mot anfall forbundet med tuberøs sklerose-kompleks (TSC) hos pasienter ≥2 år.
Dosering: Behandling skal initieres og følges opp av lege med erfaring i behandling av epilepsi. Doseøkninger til mer enn 10 mg/kg/dag må gjøres basert på nytte og risiko og i samsvar med den fullstendige overvåkingsplanen. LGS og DS: Anbefalt startdose: 2,5 mg/kg to ganger daglig (5 mg/kg/dag) i 1 uke. Vedlikeholdsdose: 5 mg/kg to ganger daglig (10 mg/kg/dag). Maksimaldose: 10 mg/kg to ganger daglig (20 mg/kg/dag). TSC: Anbefalt startdose: 2,5 mg/kg to ganger daglig (5 mg/kg/dag) i 1 uke. Vedlikeholdsdose: 5 mg/kg to ganger daglig (10 mg/kg/dag). Maksimaldose: 12,5 mg/kg to ganger daglig (25 mg/kg/dag). Seponering: Dosen skal reduseres gradvis. 10 % reduksjon per dag i 10 dager er undersøkt, men langsommere eller raskere nedtitrering kan være nødvendig. Glemt dose: Ved én eller flere glemte doser, skal disse ikke kompenseres for. Dosering gjenopptas ihht. behandlingsplan. Ved glemte doser i mer enn 7 dager skal det opptitreres til terapeutisk dose. Spesielle pasientgrupper: Nedsatt leverfunksjon: Forsiktighet utvises med moderat eller alvorlig nedsatt leverfunksjon (Child-Pugh B el. C) og lavere startdose, vedlikeholdsdose og maks. dose anbefales. Se SPC for doseringsanbefalinger. Nedsatt nyrefunksjon: Ingen erfaring ved terminal nyresykdom. Ikke kjent om cannabidiol kan fjernes ved dialyse. Barn: LGS og DS: Ikke relevant for barn < 6 måneder. Sikkerhet og effekt hos barn ≥ 6 måneder til < 2 år er ikke fastslått. TSC: Ikke relevant for barn < 1 måned. Sikkerhet og effekt hos barn ≥ 1 måned til < 2 år er ikke fastslått. Eldre: Ikke fastslått om personer > 55 år har annen effekt enn yngre. Startdose bør være i nedre doseområde pga. høyere forekomst av nedsatt lever-, nyre- eller hjertefunksjon og samtidig sykdom eller annen legemiddelbehandling. Annet: Behov for dosejusteringer av cannabidiol eller samtidig antiepileptika bør evalueres med tanke på interaksjoner. Administrering: Til oral bruk. Mat kan øke konsentrasjonen og dosene må derfor tas konsekvent enten med eller uten mat, med lik sammensetning, også under ketogen diett. Kontraindikasjoner: Overfølsomhet overfor noen av innholdsstoffene Transaminaser > 3xULN og bilirubin > 2xULN. Forsiktighetsregler: Hepatocellulær skade: Kan gi doserelatert økning av levertransaminaser, vanligvis i løpet av de første 2 mnd., men er sett opptil 18 mnd. etter behandlingsstart, særlig ved bruk av valproat. Klobazam kan også øke
levertransaminaser. Dosejustering eller seponering av valproat eller dosejustering av klobazam skal vurderes. Økte transaminasenivåer på > 3xULN sammen med bilirubin > 2xULN uten alternativ forklaring, er en viktig prediktor på alvorlig leverskade og behandling må evalueres. Se SPC for informasjon om overvåkning av leverfunksjonen. Ved kliniske tegn eller symptomer på nedsatt leverfunksjon, skal serumtransaminaser og total bilirubin måles umiddelbart, og behandlingen avbrytes eller seponeres. Cannabidiol skal seponeres hos alle som får transaminaser > 3xULN og bilirubin > 2xULN, samt ved vedvarende forhøyning på > 5xULN. Somnolens og sedasjon: Kan forekomme, vanligvis tidlig i behandlingen og kan forsvinne ved fortsatt behandling. Høyere forekomst ved samtidig bruk av klobazam. Kan potenseres av andre CNS-dempende midler, inkl. alkohol. Økt anfallsfrekvens: Kan forekomme, noe som kan kreve dosejustering av cannabidiol og/eller samtidig antiepileptika, eller seponering av cannabidiol ved negativt nytte/risikoforhold. Suicidal atferd og selvmordstanker: Er sett ved bruk av antiepileptika. Pasienter bør overvåkes for tegn på suicidal atferd og selvmordstanker, og hensiktsmessig behandling vurderes. Pasienter/omsorgspersoner bør søke hjelp ved tegn på suicidal atferd og selvmordstanker. Vekttap: Kan forårsake vekttap eller redusert vektøkning, noe som kan gi redusert høydevekst. Sjekkes regelmessig. Inneholder etanol og benzylalkohol: Henholdsvis 79 mg/ml etanol og 0,0003 mg/ml benzylalkohol. Inneholder sesamolje: Kan i sjeldne tilfeller gi alvorlige allergiske reaksjoner. Interaksjoner: Dosejustering kan bli nødvendig ved samtidig bruk av CYP3A4- eller CYP2C19-induktorer, UGT-hemmere og antiepileptika. Epidyolex kan også påvirke andre legemidler, inkludert CYP-, UGT- og P-gp-substrater. Bivirkninger: Svært vanlige: Nedsatt appetitt, diaré, oppkast, fatigue, feber, somnolens Vanlige: Kvalme, utslett, pneumoni, urinveisinfeksjon, økte leverenzymer, hoste, letargi, krampeanfall, aggresjon, irritabilitet, vekttap. Se felleskatalogtekst eller preparatomtale (SPC) for mer informasjon. Innehaver av markedsføringstillatelsen: Jazz Pharmaceuticals Ireland Ltd., For mer informasjon kontakt Jazz Pharmaceuticals: medinfo-int@jazzpharma.com Pakninger og priser 10.07.2023: 100 ml (1 × 100 ml flaske): kr. 15544,90 (priser og ev. refusjon oppdateres hver 14. dag). Refusjon: H-resept: N03A X24 Cannabidiol Refusjonsberettiget bruk: Der det er utarbeidet nasjonale handlingsprogrammer/nasjonal faglig retningslinje og/eller anbefalinger fra RHF/LIS spesialistgruppe skal rekvirering gjøres i tråd med disse. Vilkår 216: Refusjon ytes kun etter resept fra sykehuslege eller avtalespesialist. Dato for utforming: Juli


Inntrykk fra 4 uker som delegat/barnelege på den internasjonale Røde Kors-komiteens (ICRC) feltsykehus i Rafah i juni 2024.
Tekst og foto: Harald Hurum, overlege Sykehuset Østfold

På feltsykehuset samarbeidet vi med mange lokale kolleger. Her er jeg sammen med Dr Hussam. Han er palestinsk pediater med utdannelse fra Egypt og Gaza. Flere av de lokale legene og sykepleierne hadde pediatrisk erfaring

Fra takterrassen av huset der rødekorsdelegatene bodde, vegg i vegg med feltsykehuset, var det god utsikt til omgivelsene. Området lå på grensen til den «humanitære sonen» og var omgitt av flyktninger i provisoriske teltleirer.
SUMUD
I Gaza lærte jeg et nytt begrep. Det vil si, hva det het lærte jeg ikke før jeg kom hjem, men hva det var oppdaget jeg mer og mer under oppholdet: Evnen det palestinske folket har til å overleve, ikke la seg knekke, ikke bli bitre og hatske, ikke gi opp, men stå oppreist i motgang. Kanskje vi på norsk ville kalt det «motstandskraft» eller «overlevelsesevne».
På feltsykehuset ble jeg godt kjent med de lokale kollegene, og hver dag ble jeg imponert over pågangsmotet og evnen til å holde humøret oppe. De fleste av dem har mistet hjemmene sine, bor i provisoriske teltleirer med familiene sine og må bruke opptil 2 timer på å komme seg til og fra jobb.
I krigen mellom Israel og Hamas begås det hver dag enorme overgrep mot befolkningen.
Sivile utsettes for direkte krigshandlinger i et samfunn der infrastrukturen har brutt sammen etter 7 oktober 2023. Ingen skoler, ingen politimyndighet, ingen vannforsyning, ingen sanitær -og renovasjonstilbud, istykkerskutte helseinstitusjoner, ingen vaksinering, manglende medisinsk oppfølging av kronisk syke, manglende mat-forsyning, ingen offentlig transport, et ikke-fungerende bankvesen… En befolkning på cirka 2,3 millioner mennesker er sperret inne på et område som er 40 km langt og 10 km bredt, uten anledning til å komme seg ut og i sikkerhet og uten mulighet til å få innført alt det samfunnet normalt trenger.
Begreper som «steg-for-steg-folkemord» brukes av mange om denne situasjonen. Jeg synes ordene til min hjemby Fredrikstad’s store sønn Hans Nielsen Hauge kan passe: I Gaza kjenner man virkelig «verdens daarlighet» på kroppen.
BRUK FOR MEG?
Som barnelege trodde jeg at jeg ville møtte mange pediatriske problemstillinger på sykehuset. Det gjorde jeg ikke i starten, 90 % av pasientene var traumepasienter, brorparten menn utsatt for skudd og bomber, men også mange kvinner og barn. Ved flere anledninger måtte vi ta imot et massivt antall sårede og skadde, på det meste cirka 70 pasienter i løpet av 1-2 timer hvorav 22 døde eller døende. Det er utfordrende for et sykehus med 60 senger. Ikke bare i forhold til å triagere, prioritere og behandle, men også i møte med en stor mengde familie og pårørende med masse følelser og «sydlandsk temprament». Igjen ble jeg dypt imponert over mine lokale kolleger.
De rent medisinske problemstillingene kunne ofte håndteres poliklinisk eller med intravenøs rehydrering i mottaket. I løpet av de tre første månedene ICRC-feltsykehuset i Rafah har eksistert, er det registrert nærmere 20 000 polikliniske konsultasjoner.
Jeg tror de medisinske problemstillingene vil bli mer framtredende etter som tiden går hvis krigen vedvarer. Det var en pågående Hepatitt A-epidemi, og gitt boforholdene er det

Ambulansene ved inngangen til sykehuset.
Ambulansearbeiderne gjorde en veldig viktig jobb. Med livet som innsats henter de alvorlig skadde til sykehuset.

Barn skytes i ryggen i Gaza. Dette barnet fikk ingen alvorlige indre skader, selv om kulen ble liggende midt i thorax. Englevakt?
bare et spørsmål om tid før nye epidemier oppstår: Meslinger, kolera…
Jeg fant raskt ut at jeg måtte ut av den pediatriske komfortsonen om jeg skulle gjøre nytte for meg. Jeg bidro derfor i mottaket også med mottak av skadde (barn) og oppfølging av innlagte, medisinske pasienter. Sykehuset har også fødetilbud, og vi hadde 1-3 fødsler daglig, et tall som nå er synkende. Nyfødte som trengte intensiv eller langvarig behandling måtte vi sende til andre sykehus etter at vi hadde stabilisert og startet antibiotika/væske.
Feltsykehuset er sparsomt utstyrt for små syke barn. Vi hadde oksygenkonsentrator, inhalatorer og asfyksibord, men ingen CPAP, kuvøser eller monitoreringsutstyr.
Oppholdet i Gaza ble en viktig påminnelse for meg om hvor godt vi har det i Norge og hvor lite vi har å klage på. Å bidra med medisinsk og ikke minst moralsk støtte til befolkningen føltes veldig meningsfylt. Det var godt å være der, og bedre og bedre for hver uke som gikk.
Jeg kom som gjest til Gaza, og en viktig del av oppdraget er å legge til rette for de lokale kollegene og gi de mulighet til å utføre sin jobb. Det er de lokale – sykepleiere, jordmødre, leger, ambulansesjåføren, renholderne - som er de virkelige heltene. Ingen grunn til å komme med pekefinger eller kritikk om de løser ting annerledes enn her hjemme.
TRYGT?
Ja, sikkerheten er et spørsmål for mange, men Røde Kors gjør det de kan for å ivareta sine ansatte og har tett kontakt med de stridene parter. Jeg følte meg stort sett trygg på tross av lavtflyvende israelske droner, jagerfly, skuddvekslinger og bombenedslag, noen ganger ubehagelig nær sykehuset.
BURDE VI BLITT HJEMME?
Ja, kanskje om vi bare tenker på egen sikkerhet - men vi må trene oss på å tenke større tanker enn det. For oss som lever et smerte- og problemfritt liv i Norge er det vanskelig å forstå hvilke lidelser palestinerne i Gaza gjennomgår nå og hvilken framtid de går i møte når denne krigen er over. Vi må hjelpe.





VIKTIG: Morsmelk er spedbarnets beste føde og om ammingen avbrytes kan det være vanskelig å fortsette. Bruk av morsmelkerstatning kan minske tilgangen til morsmelk. Tenk på fordelene med amming før du introduserer morsmelkerstatning. Et variert kosthold er gunstig for ammende mødre. Foreldre skal informeres av helsepersonell når det gjelder barnets kost. Det er meget viktig å følge instruksjoner for tilberedning. Feil håndtering kan påvirke barnets helse. Nutramigen produktene er næringsmidler til spesielle medisinske formål og skal brukes under medisinsk tilsyn. Produktene skal ikke gis parenteralt.
*Varemerke tilhører Mead Johnson og Company, LLC. ©2024 Mead Johnson & Company, LLC. Alle rettigheter forbeholdes

Montebellosenteret er en nasjonal helseinstitusjon som tilbyr hjelp til livsmestring for kreftrammede og pårørende. Senteret arrangerer ukeskursopphold for mange ulike diagnoser og temaer. Familiekursene er et unikt tilbud, hvor både foreldrene og barn mellom 0-18 år deltar. Hvert år arrangeres det et kurs for familier, hvor et av barna har kreft.
Tidligere besøkt: 2023; 42 (2) Geilomo 2023; 43 (3) Beitostølen 2024; 44 (1) CatoSenteret
Montebellosenteret
Tekst: Maria Munsters, kommunikasjonsrådgiver og Marianne Straume, spesialist i klinisk psykologi
Montebellosenteret ligger i Mesnali og er en privat stiftelse, opprettet av staten (Helse- og omsorgsdirektoratet) i samarbeid med Radiumhospitalet i 1990. Montebellosenteret (MBS) er en landsdekkende helseinstitusjon og alle som har eller har hatt kreftsykdom kan søke om opphold. MBS får driftstilskudd fra staten i form av døgnramme. Mange private gavemidler har gitt senteret den standarden den har i dag. Gründeren til Montebellosenteret er Prof. dr.med., dr.h.c. Jan Vincents Johannessen.

Hvordan søker familier om opphold Familiene søker selv om opphold ved å sende et digitalt søknadsskjema via www.montebellosenteret.no. Lege sende en legeerklæring og dokumentasjon for pårørende. Opphold og reise betales av det offentlige gjennom folketrygden. Kurs arrangeres i samarbeid med Barnekreftforeningen og Klinikk for krisepsykologi i Bergen. Helt fra starten har Marianne Straume, spesialist i klinisk psykologi ved klinikken vært faglig ansvarlig for familiekurset.
Viktig med sosial støtte «Sosial støtte er en av de viktigste beskyttende faktorene når mennesker har opplevd eller står i krevende livssituasjoner», forteller Marianne Straume
«Samtidig erfarer vi som møter mennesker i krise at mange opplever for lite støtte i nettverket sitt. Når barn får kreft beskriver familiene ofte mye støtte i tiden rundt diagnosen, men at denne avtar ganske raskt. Mange kjenner seg igjen i beskrivelsen «sympatibølgen og ørkenvandringen», der ørkenvandringen betegner hvordan det oppleves når hverdagen med et kreftsykt barn virkelig røyner på»
Når barn rammes av kreft splittes mange familier opp fordi behandling eller isolasjon krever at barnet tilbringer tid på sykehus med en eller begge foreldre, mens søsken er igjen hjemme med den andre forelderen eller andre omsorgspersoner. Mange barn er også mentalt og fysisk svekket av behandlingen, slik at hverdagen deres i lengre perioder er endret selv når de er hjemme. Det er en ekstra belastning for de unge, spesielt søsken, at planer plutselig blir avlyst og at positive ting som andre familier kan delta på, kanskje ikke blir mulig på lang tid.


En krevende hverdag for familier med et kreftsykt barn Hverdagen for alle medlemmer av den nære familien er i perioder sterkt preget av psykisk og fysisk stress, og reaksjoner som usikkerhet/sterk bekymring, kognitive endringer, frykt og tristhet. Det er en svært krevende hverdag der mange foreldre erfarer at de det er flere behov i familien enn de kan klare å dekke. Når behandlingen strekker seg over måneder og år blir dette en enorm belastning for familiene.
En stor verdi av å møte og dele erfaringer med likesinnede
Familiekursene på Montebellosenteret har som mål å møte noen av de behovene familiene til kreftsyke barn har. Vi vet at likepersonstøtte er et behov hos de fleste som rammes av kriser og traumatiske hendelser fordi det har en stor verdi å kjenne seg sett og forstått. Mange savner dette i sitt naturlige nettverk. Likepersonstøtten settes inn i en faglig ramme for å styrke familiens mestring.
Foreldrene får undervisning for å øke forståelsen av sine egne reaksjoner, hvordan parforholdet blir satt under stort press og hvordan barn og spesielt søsken opplever sin situasjon. Det er også lagt vekt på mestringsstrategier for egne reaksjoner, utfordringer i parforholdet, i familiesamspillet, nettverket og hvordan snakke med barn om vanskelige tema. Disse temaene blir fulgt opp i samtalegrupper der forelderene får mulighet til å drøfte viktige tema sammen med andre i samme situasjon. Møtene beskrives som svært verdifulle. De opplever å bli forstått, at andre orker å lytte og at de kan dele verdifulle erfaringer. Vi ser at foreldrene også snakker mye sammen utenom det faglige programmet. Noen forteller at det er lettere å le og ta pauser fra bekymringer og stress når de andre forstår hvordan hverdagen deres oppleves.



Også for barn og unge er det viktig å dele erfaringer Barn og unge er også del av det faglige programmet. Alle mellom 6 og 18/20 år møtes 4 ganger i samtalegrupper der de er inndelt etter alder og om de er søsken eller pasienter. De unge har kanskje enda mindre mulighet enn foreldrene å få møte og dele erfaringer med andre i samme situasjon. Vi erfarer også på hvert eneste kurs at barn og unge ikke snakker med de andre om å være syk eller søsken til en med kreft, selv i en sammenheng der de vet at de andre er i samme situasjon. I samtalegruppene deltar de imidlertid med egne erfaringer, deler tanker og følelser, lytter til de andre og viser hverandre omsorg og støtte. Mange barn og unge har ingen, eller få arenaer der de kan dele dette fordi de også beskytter foreldrene sine. Det er vanlig at de unge sier at de ikke kan fortelle foreldrene om hvordan de egentlig har det fordi de kan bli lei seg eller at de har så mye å tenke på allerede. «Jeg vil ikke legge sten til deres byrde» sa en jente på 16 år i en


søskengruppe da vi spurte om hun hadde fortalt noe som var vanskelig til sine foreldre.
Positive opplevelser i trygge rammer
Familiekurset tilbyr også et omfattende fritidsprogram for de unge. Aktivitetene tilpasset det enkelte barns muligheter og begrensninger, og på kveldene arrangeres positive aktiviteter som familiene kan delta på sammen og barna danner nye vennskap.
Rammene rundt disse kursene er også viktige. Det skal være lite sykehuspreg og familiene skal få en positiv opplevelse sammen uten at foreldre må bruke krefter de ikke har på for eksempel matlaging og planlegging. De kan i større grad ivareta voksenbehov disse dagene når de vet at barna har det bra og er godt ivaretatt.

Les mer om NovoPen®
Vær oppmerksom på at hvis NovoPen Echo® Plus ikke brukes på riktig måte kan dette ha betydning for doseringen av legemidlet. * Kompatibel med insulin som er tilgjengelig i Penfill® 3 ml sylinderampulle fra Novo Nordisk.




Paidos-redaksjonen var tungt representert i arrangementskomiteen. Her kommer tidenes minst nøytrale bidereportasje. Vi konstaterer ubeskjedent at det var mer som gikk bra enn det som skar seg. Tusen takk til alle som deltok for super stemning!
Dino sjekker inn!
Fredrikstad barne- og ungdomsteater fikk fart på rockefoten i forsamlingen da de åpnet møtet med teatersnutter, sang og dans fra forestillingen Olsenbanden Jr på Rocker’n.





Vårmøtet hadde fått tittelen «Et friskt pust i en syk verden». Programmet spente fra funksjonelle lidelser og barnepalliasjon via lungesykdommer og rus til stabilisering med intakt navlesnor, BPD og katastrofepediatri. Her er et knippe av foreleserne:

Et vellykket vårmøtes aller viktigste ingrediens: Glade, engasjerte og lydhøre møtedeltakere!
Styrets time: Ny logo ble (utrolig nok!) enstemmig vedtatt, men styret forsikret om at «liten pike vill i skolen» ikke skal gå helt av med pensjon







Denne festmiddagen vil det gå gjetord om! Sang, fiolinspill, fantastiske taler, trylling og BUKTALING! Smilet gikk rundt, og latterkrampa har ennå ikke helt sluppet taket.






Barnelegeforeningens nyeste æresmedlem: Inger Elisabeth Silberg. Vel fortjent! Gratulerer!








Vindstillejuninattmedvakkert kveldslysoverIsegranogHåpets rundtkatedralskapteenflottramme båthuhsetfestmiddagenidetgamle
ISSUE JUNE / JULY
DOI: 10.1111/apa.17262

Baxendale examined the literature on the effect that pubertal suppression had on cognitive and behavioural functions, including both animal and human studies.1
Animal studies revealed the sex-specific effects of puberty suppression on neuropsychological functions, with no evidence of them being fully reversible. No human studies had systematically and adequately explored the impact of these treatments on neuropsychological function, but there were suggestions of detrimental effects on intelligence quotient. Landén comments on the findings and calls for more research on puberty suppression of children with gender dysphoria. 2 https://doi.org/10.1111/apa.17150, https://doi.org/10.1111/apa.17189

More than one in six parents had moderate depression or more if their children had type one diabetes, according to a meta-analysis by Ryan et al.,3 which covered 2044 participants from five continents. An editorial by Johnny Ludvigsson points out that managing type 1 diabetes is complicated and heavy, without breaks, and parents may feel that their best is not good enough when it comes to their child's metabolic control.4 Very strict guidelines may reduce the quality of life of both the patients and their parents and that psychological support is important, so that families can learn to live with, not for, diabetes. https://doi.org/ 10.1111/apa.17059, https://doi.org/10.1111/apa.17188

Drowning had increased in children aged 5–14 years 2021–2022, compared to just before the COVID-19 pandemic. This could be due
to missing out on swimming lessons during lockdown.5 Although the trends for other fatal injuries were promising, there was still much room for improvement and Oates lists five suggestions that could reduce fatal injuries and improve child safety. An Italian study by Bellini et al.6 looked at factors that may play a role in the prognosis of fatal and non-fatal paediatric drowning. One finding was that children who did not live permanently by the sea faced a higher risk. https:// doi.org/10.1111/apa.17063, https://doi.org/10.1111/apa.17016

Goossens et al.7 studied all preterm infants who died between September 2016 and December 2017 in Flanders and Brussels, Belgium, and compared their details with a study from August 1999 to July 2000. They found that deaths had become more prevalent in infants born at the limits of viability, possibly due to changing attitudes towards periviable births. However, there had been no changes in the cause of death or end-oflife decisions during this period. https://doi.org/10.1111/apa.17153

Bibliotherapy is a therapeutic method that uses books to provide assistance and promote mental and emotional well-being. Edwin et al. 8 report that a sevenday bibliotherapy intervention significantly reduced anxiety levels among 60 hospitalised children aged 5–12 years in Tamil, India. Each child participated in two, 20-min sessions every day, which were adapted to their age. The results seemed promising, but the lack of a control group made it challenging to draw conclusions. https://doi.org/10. 1111/apa.17154
Figures: istockphoto
DOI: 10.1111/apa.17340

Children who met sleep guidelines and went to bed early had better metabolic syndrome scores, insulin resistance and insulin levels than children who did not meet the guidelines and went to bed later. These were the key findings of a study by Nilsson et al.,1 who measured the associations between sleep patterns and cardiometabolic risk factors in 411 Swedish 9-year-olds. Xue and Benedict2 comment on the findings. https://doi.org/10.1111/apa.17254

Hellénius et al. 3 investigated the relationship between sarcopenic obesity and muscle strength in 67 8-year-old Swedish children and their parents. The authors were surprised to discover that abdominal obesity could already be observed in 13% of the girls and 35% of the boys. It was also seen in 53% of the mothers and 34% of the fathers. Independent, negative associations were found between muscle strength and waist circumference in the children and parents and clusters of reduced muscle strength were observed in families. https://doi.org/10.1111/apa.17274

Suihko et al.4 compared children with the Finnish type of congenital nephrosis, who underwent a late nephrectomy, when they weighed 10 kg, or traditional nephrectomy treatment at 7 kg. The aim was to shorten their time on dialysis before a kidney transplant could be performed. Both groups had comparative outcomes, but
the infants who underwent a late nephrectomy were less dependent on feeding tubes and had better motor development during the first months after their transplant. An editorial by Böckenhauer and Boyer5 discusses the treatment dilemmas involved in congenital nephrotic syndrome. https://doi.org/10.1111/apa.17294

The prevalence of spina bifida decreased from 5.2 to 1.2 per 10 000 births in Sweden between 1973 and 2021, according to a nationwide register study by Andersson et al.6 Survival during the first year of life rose from 75% to 94%. The authors also found that the differences in mortality between decades were low in children aged 2–18 years and adults. Deaths during childhood were mainly associated with malformations, hydrocephalus and infections. Adult causes also included kidney failure, bladder cancer, self-inflicted injuries and substance abuse with suicidal or unclear intent. The authors state that interventions for adults with spina bifida need to be improved. https://doi.org/10.1111/apa.17275

Family integrated care was developed in high-income countries, but Kabajassi et al.7 carried out a study to see if it could be adapted to a low-resource neonatal hospital unit in Uganda. The authors interviewed mothers and healthcare providers to find facilitators and constraints to this care model. The facilitators included reducing healthcare workloads and improving neonatal outcomes by involving mothers and also making them feel empowered. Perceived constraints included mothers being unable to learn new skills and finding their new responsibilities stressful and healthcare professionals not trusting the mothers' assessments. Hildenwall comments on the findings. 8 https://doi.org/10.1111/apa.17182
Figures: istockphoto.
ISSUE SEPTEMBER
DOI: 10.1111/apa.17356
ISSUE HIGHLIGHTS
OVERWEIGHT AND OBESITY INCREASED AMONG NORWEGIAN BOYS DURING THE COVID - 19 PANDEMIC

Balthasar et al.1 analysed data collected on more than 78 000 children by child and school health centres during 2010–2022, to explore trends in child overweight and obesity in Bergen, Norway. They found that during the pre-pandemic period of 2010–2019, overweight and obesity plateaued in girls and decreased in boys. However, these weight issues then increased among prepubertal boys during the COVID-19 pandemic years of 2020–2022. https://doi.org/10.1111/apa.17323
FAECAL MICROBIOTA TRANSPLANTATION FOR CHILDHOOD DISORDERS

A number of diseases have been associated with imbalances in the intestinal microbiota. Lauwers et al.2 carried out a systematic review of 50 papers, to explore the indications, safety profiles and future directions for using faecal microbiota transplantation for different childhood disorders. Using transplants to treat recurrent Clostridioides difficile infections was demonstrated to be safe and effective, despite some severe events. However, the authors concluded that there were still limited data for using transplantation for other conditions, such as inflammatory bowel disease and obesity. Abrahamsson comments on the findings.3 https://doi.org/10.1111/ apa.17167

Adolescents with surgically treated hydrocephalus were found to have a lower health- related quality of life and more perceptual
visual dysfunction than their peers. The findings come from a Swedish study by Najim et al., 4 who evaluated 23 adolescents with hydrocephalus and 31 controls.4 The authors concluded that individuals with infantile hydrocephalus need more follow ups related particularly to perceptual visual dysfunction and quality of life. https://doi. org/10.1111/apa.17315

Routines on safe skin-toskin contact and preventing sudden unexpected postnatal collapses either did not exist or varied widely in Dutch perinatal centres. A survey by Bergman et al. 5 found that the protocols that were available often lacked the latest published insights on safe skin-toskin contact and particularly, how to prevent sudden unexpected postnatal collapses in hospitals. The authors stress that, although these collapses are rare in the Netherlands, there is still a need for uniform, multidisciplinary guidelines. https://doi.org/10.1111/apa. 17292

Understanding where children die is crucial, so that tailored end-of-life care services can be well organised and provided. A populationbased study by Nilsson et al.6 found that just under threequarters (74.7%) of Swedish children who died from 2013 to 2019 were in hospital at the time. The study also compared children who died during their first year of life and those who died at 1–17 years of age. It did not find any differences between these age groups. The authors have called for a national policy regarding paediatric palliative care structures that match children's needs. https://doi.org/10.1111/ apa.17308
Figures: istockphoto
“Hva skjer gutter?”
spør Finn.
Men når Finn ser nærmere etter, er vennene hans våte av svette.
“Så rart, tenker Finn, jeg svetter ikke, selv om jeg er veldig varm.”

HVILKET SYMPTOM PASSER BEST I FINNS SITUASJON?
Er du nysgjerrig på svaret? Skan QR koden eller gå inn på www.sjeldne-sykdommer.no/ nb/fabry-sykdom/symptomer og les mer om symptomer på Fabry sykdom.
Fabry er en sjelden lysosomal sykdom som kan debutere med symptomer i tidlig barnealder. Symptomene er ofte diffuse og lette å overse. Ubehandlet vil sykdommen kunne medføre skade på nyre, hjerte og hjerne i tidlig voksen alder. Fabry verifiseres med enzymanalyse og gentest.


Aminosyrebasert ernæring med unike alderstilpassede løsninger for kostbehandling ved kumelkallergi og multimatvareallergi
Neocate LCP fra 0-12 mnd.
Neocate Spoon tilskudd fra 6 mnd., konsistens for skje
Neocate Junior fra 1 år, tre gode smaker for bedre compliance1



Samme innhold, nytt design


